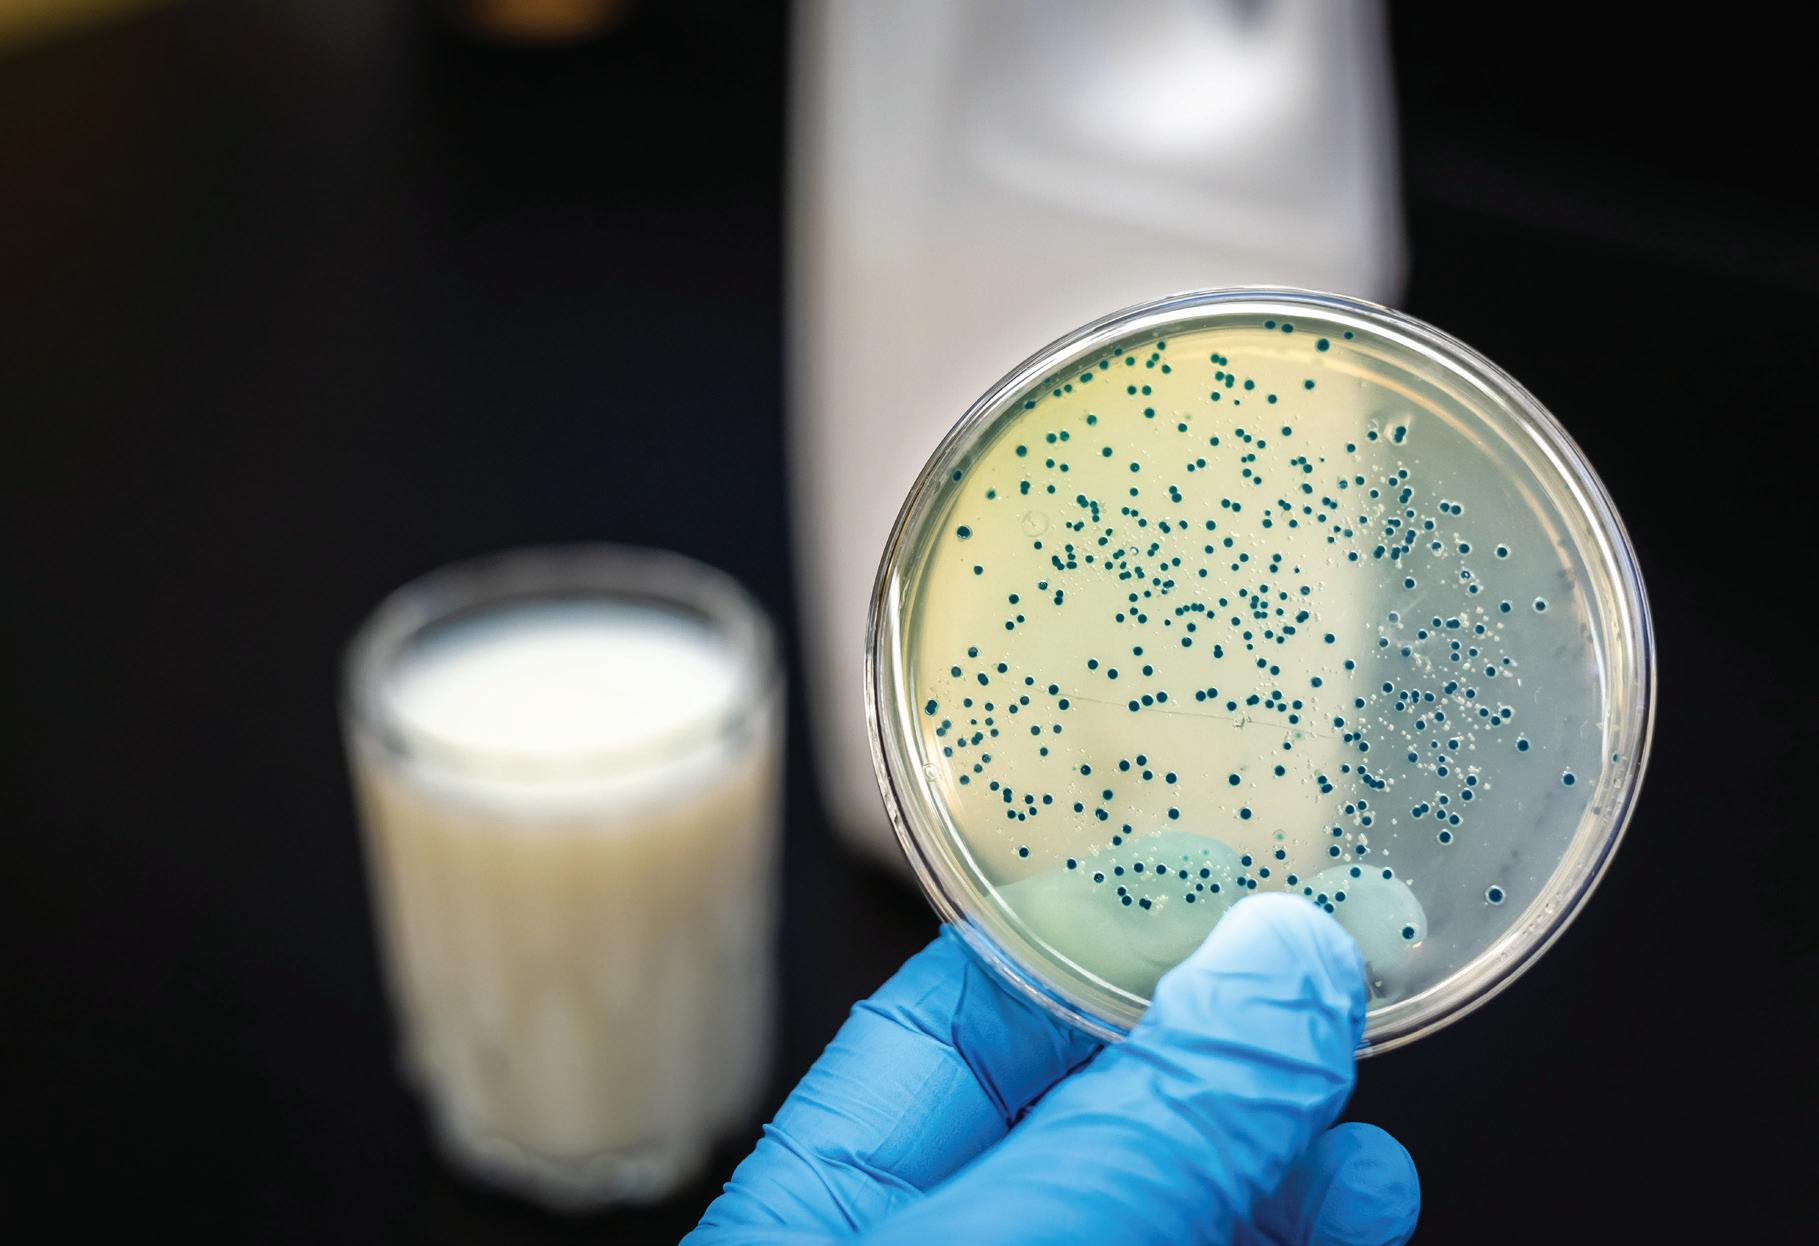

Fim de semana, 18 e 19 outubro 2025 | Ano 23 - Nº 3955 | R$ 5,00 (dia útil) R$ 9,00 ( m de semana)
OLHAR AO TURISMO DE NATUREZA


REGIONAL Estudo aponta potenciais e lacunas do Vale
Diagnóstico estadual mostra contraste entre força econômica e fragilidades, com baixo saneamento e baixo preparo para enfrentar desastres.

Pesquisa inédita mostra tração do mercado imobiliário do Vale do Taquari em 2025. No primeiro semestre, os lançamentos cresceram 400% ante 2024 e Lajeado concentrou 90% das novas unidades. Mi-
nha Casa Minha Vida, compactos e retorno dos imóveis de luxo puxam alta. O levantamento indica oportunidades e também expõe riscos devido ao juros, além das restrições nos financiamentos. PÁGINAS

| 10 e 11















VINI BILHAR
Florestal mira 90 anos com mais de 400 itens

O novo Perfil Socioeconômico do Vale do Taquari traça um retrato preciso e inquietante. De um lado, destaca-se a força econômica: PIB superior a R$ 19 bilhões, oitava maior economia do RS, setores industrial e de serviços sólidos e bons índices em saúde e renda. De outro, persistem gargalos históricos e desafios agravados pelos desastres climáticos recentes.
O saneamento é o caso mais crítico: só 8,6% da população tem acesso à rede de esgoto — índice incompatível com o peso econômico regional. A carência nessa área compromete o meio ambiente, a saúde pública e a capacidade de atrair
Crescimento econômico, por si só, não garante desenvolvimento equilibrado e resiliente”
investimentos. A vulnerabilidade climática também preocupa: um quinto dos moradores foi diretamente atingido pelas enchentes de 2023 e 2024, e seis dos dez municípios mais afetados do Estado estão no Vale.
O estudo aponta ainda envelhecimento acelerado, desigualdades territoriais e dependência de cadeias produtivas tradicionais. Ao mesmo tempo, revela oportunidades: uso da biomassa para energia, retomada da hidrovia e diversificação industrial.
A mensagem é clara: crescimento econômico não basta. É preciso transformar diagnósticos em políticas públicas efetivas, planejadas com base em dados e articuladas entre municípios, Estado e sociedade. O perfil regional não deve ser apenas um relatório — é o mapa para um futuro mais equilibrado, sustentável e preparado para crises.
à

Av. Benjamin Constant, 1034, Centro, Lajeado/RS grupoahora.net.br / CEP 95900-104
FAÇA SUA
Editor-chefe da Central de Jornalismo: Felipe Neitzke
Contatos eletrônicos:
assinaturas@grupoahora.net.br comercial@grupoahora.net.br faturamento@grupoahora.net.br financeiro@grupoahora.net.br centraldejornalismo@grupoahora.net.br atendimento@grupoahora.net.br
Os artigos e colunas publicados não traduzem necessariamente a opinião do jornal e são de inteira responsabilidade de seus autores. Impressão Zero Hora Gráfica
Diretor Executivo: Adair Weiss
Diretor Editorial e de Produtos: Fernando Weiss
ABRE ASPAS
“Ser patrão de um CTG é um orgulho imenso”
Ademar Forster, 37 anos, é opatrãodoCTGTropilha Farrapa,deLajeado.Há uma década envolvido na organizaçãodasatividades artísticas e culturais da entidade,elefoieleitono mde2024paraassumir oprincipalcargodo tradicionalismo local
Ezequiel Neitzke ezequiel@grupoahora.net.br
Está há quanto tempo à frente da entidade?
Entrei no CTG em 2014. Em 2015, fui convidado a integrar o grupo de coordenação da invernada adulta, na qual permaneci até o fim de 2024. Foi então que montei a chapa e fui eleito patrão, ao lado do meu vice, Andreas Fink.
O que significa, pessoalmente, ser patrão do CTG?
Ser patrão dessa entidade é um orgulho imenso, principalmente por tudo o que ela representa e construiu ao longo da história. Sou um sócio como qualquer outro, mas tenho o compromisso de elevar o CTG ao mais alto nível possível dentro do movimento tradicionalista.
Qual é a lembrança mais especial que o senhor guarda da entidade?
Tenho lembranças marcantes das conquistas das nossas invernadas artísticas, campeiras e também dos competidores individuais. Cito a Caroline Scariot, que conquistou o posto de 2ª Prenda do Estado em 2016/2017, e a Jéssica Herrera, 1ª Prenda do Estado em 2017/2018. Outro momento especial foi o segundo lugar no Enart, na Força B, com a invernada adulta. Mas o que mais me marcou foi o trabalho realizado durante a enchente de maio de


2024. Nosso CTG se tornou um dos centros de distribuição de donativos para os desabrigados. Ver a união de voluntários, bombeiros e pessoas da comunidade foi emocionante.
Quais são os principais desafios enfrentados ao longo dessa caminhada?
O maior desafio é manter os jovens ativos na entidade. Hoje, a tecnologia — com celulares e internet — acaba desviando a atenção deles. Nosso esforço tem sido criar oportunidades e espaços que despertem o interesse dos jovens em participar e viver o CTG.
Como o CTG contribui para aproximar as novas gerações da tradição?
Visitamos escolas, participamos de eventos comunitários e promovemos integrações com diferentes culturas. Essas ações despertam curiosidade e incentivam os jovens a se envolver com o tradicionalismo.
De que forma o CTG se conecta com a comunidade além do tradicionalismo?
A entidade participa de atividades conjuntas com outras culturas e instituições.
O maior desa o é manter os jovens ativos na entidade. Hoje, a tecnologia acaba desviando a atenção deles. Nosso esforço tem sido criar oportunidades e espaços que despertem o interesse dos jovens”
Também cedemos nosso galpão para uso das escolas municipais e da administração pública em eventos internos. O CTG Tropilha Farrapa está sempre de portas abertas para a comunidade.




rodrigomartini@grupoahora.net.br
RODRIGO MARTINI
Todos perdem com ofensas e “terra arrasada”
Uma Comissão Parlamentar de Inquérito (CPI) é sempre indigesta. Ninguém em sã consciência “torce” por uma CPI. Mas vire e mexe é necessário sacudir o poder público para verificar se as coisas flutuam de acordo com a lei e a vontade do pagador de impostos. Para isso serve o Legislativo, inclusive. Portanto, não há nada de anormal nesta nova CPI em Lajeado, instaurada de forma oportuna pelos vereadores de oposição em meio às graves denúncias de supostas obras irregulares. Ora, se há desconfianças, investiguem. E se houve erros
ou crimes, que se puna. Se não ocorreu nada de errado, a vida segue. Dito isso, o contribuinte precisa estar imunizado aos discursos mais inflamados. E não permitir que tais discursos nos desconectem das nossas próprias virtudes comunitárias. A situação do lixo ainda é vergonhosa? Claro. Há outras pendengas? Lógico. Sempre haverão. E é plausível levar tudo isso em conta na hora do voto, sim. Mas a hora do voto é 2028. Até lá, não podemos permitir que se instale um sentimento de “terra arrasada”, concretado de forma maquiavélica por alguns poucos agentes públicos que insistem em discursos
recheados de exageros e ofensas pessoais. Não é esse o caminho. Todos perdem com essa visão distorcida da cidade. Perde o comerciante, a empresária, o turista, o frentista, o professor, o investidor, o aposentado, a dona de casa. Todos perdem com um falso e irresponsável cenário de terra arrasada, ainda mais diante dos recentes impactos das enchentes à nossa confiança social e econômica. Ora, e acima de tudo, a cidade não se resume ao ente público e seus históricos e previsíveis embaraços. E tampouco à meia dúzia de servidores, ex-servidores e/ou terceirizadas. Portanto, vamos com calma!
Encontro para gritar pelas moradias (e
outras tantas demandas)



A audiência pública coordenada pela Comissão Externa Sobre Danos Causados Pelas Enchentes no RS lotou as dependências da câmara de Estrela na agradável manhã de sexta-feira. O movimento da Câmara dos Deputados é capitaneado pelo deputado federal Marcel Van Hatten (Novo), e tem na relatoria o icônico pedetista Pompeo de Matos. Outros

parlamentares, federal e estaduais, também representavam outras siglas partidárias, além de prefeitos, vereadores, prováveis candidatos, líderes regionais e comunidades em geral. Um encontro multipartidário e com boa representatividade regional, estadual e federal, reforço. Um momento importante para retomar o grito e o eco pelas milhares de moradias

TIRO
- O responsável pelo dossiê com as denúncias de supostas obras irregulares diz que tentou conversar com integrantes do governo de Lajeado ainda em fevereiro, oito meses antes da CPI ser instaurada. Segundo ele, o encontro serviria para “alertar” sobre as supostas irregularidades nas obras públicas.
- Em Estrela, a oposição anda de olho nas longas viagens de “férias” realizadas recentemente por alguns servidores municipais. E isso pode gerar dor de cabeça ao Executivo.
- Também em Estrela, a empresa interessada na construção de um estaleiro no porto fluvial já encaminhou pedido de Licença Ambiental.
- Ainda em Estrela, o clima esquentou entre a atual prefeita Carine Schwingel e o ex-prefeito Elmar Schneider durante a audiência de ontem na câmara. Em pauta, a demora na contratação e execução de obras de reconstrução.
- No dia 30 de outubro, no Gabinete da Casa Civil do Estado, o secretário estadual Artur Lemos e o secretário de Reconstrução Pedro Capeluppi recebem líderes regionais para tratar da construção da “Ponte dos Vales”, entre Estrela e Cruzeiro do Sul. E por lá estarão a prefeita Carine Schwingel (União Brasil), o prefeito Dingola (PP), e os empresários Nilto Scapin e Ângelo Fontana.
- Em tempo, ao menos três grandes grupos demonstraram interesse na construção da “Ponte dos Vales” sobre o Rio Taquari. Um é do Rio Grande do Sul.
- O governo de Encantado inaugura no dia 7 de novembro o centro de inovação municipal, o Encanta Hub. O evento inicia às 16h.
- O Executivo de Lajeado realiza Audiência Pública da Lei Orçamentária Anual (LOA) de 2026. O encontro é dia 28 de outubro, às 14 horas, na Secretaria de Educação. Em agosto foi apresentada a Lei de Diretrizes Orçamentárias (LDO), com um orçamento previsto de R$ 767 milhões para 2026, valor 15% maior do que o orçamento deste ano, estimado em R$ 654 milhões.
SUSPEITAS EM LAJEADO
CPI verifica relação entre fiscais de obras e partidos
que ainda não foram entregues às famílias que tudo perderam nas enchentes. Além disso, os participantes debateram sobre a perda de arrecadação (IPTU, ISS) dos municípios e o gasto municipal na reconstrução; a retomada da ferrovia do trigo; os novos planos diretores; dragagem de rios e arroios; melhorias no aeródromo; e apoio ao homem do campo.
Além de solicitar ao Executivo as cópias de “todos os empenhos e pagamentos realizados para a empresa PDS Obras entre 2017 e 2025 e relativos a todas secretarias e órgãos públicos”, o vereador Ederson Spohr (MDB) também pede cópia de outros serviços contratados em 2022 pelas demais secretarias municipais. Paralelo a isso, o secretário da Comissão Parlamentar de Inquérito (CPI) também solicitou ao Cartório Eleitoral informações sobre a “existência ou não de filiação partidária” de 16 servidores e exservidores públicos que atuaram como fiscais de contrato durante
o período investigado. E, de antemão, é possível afirmar que muitos possuem, sim, ligações com partidos da base aliada deste e do governo anterior. Resta saber o motivo destes questionamentos…



VINI BILHAR


“É um momento para celebrar o legado de 90 anos e, acima de tudo, olhar para frente”
A Florestal Alimentos completará em janeiro de 2026, 90 anos. Fundada em 1936, a empresa lajeadense conta com um portfólio de mais de 400 ítens, em mais de 10 segmentos e linhas de produtos. O CEO da empresa, Maurício Weiand, conversou com a coluna em uma análise do cenário atual, oportunidades e desafios da empresa e do setor de alimentos.
Tradição e inovação: qual a relação com doces e chocolates?
Maurício Weiand - A tradição segue sendo nosso alicerce, garantindo consistência, qualidade e confiança. Essa base sólida, é o que permite inovar com segurança, investindo em novos produtos, tecnologia e formatos para um consumidor mais exigente, sempre mantendo a essência de sabor, qualidade e proximidade.
Qual o papel dos investimentos em tecnologia e logística?
Weiand - Fizemos investimen-

tos significativos nos últimos anos, com destaque para a modernização da planta em Lajeado, que ganhou novas linhas de produção e automação. As melhorias aumentaram a capacidade, reduziram perdas e elevaram a eficiência. Também inauguramos um Centro de Distribuição em São Paulo, somando-se às unidades de Lajeado e Pernambuco, e seguimos
Dia do Médico: da saúde à economia
O Dia do Médico, celebrado neste sábado, 18, reconhece a dedicação e o papel desses profissionais na sociedade. Além do cuidado aos pacientes, os médicos atuam no empreendedorismo em saúde, gerindo clínicas e iniciativas que movimentam a economia. A relação médico-paciente
envolve confiança, acolhimento e orientação contínua, fundamentais para a qualidade de vida. O setor de saúde é relevante economicamente, gerando empregos e inovação, e os médicos contribuem para a eficiência do sistema, prevenindo doenças, reduzindo custos sociais e hospitalares.
avançando em sustentabilidade, com uso de energia limpa e menor emissão de gases.
Como os juros e a renda afetam o consumo e o perfil do consumidor hoje?
Weiand - O cenário é desafiador, sem dúvida, mas o consumidor brasileiro é resiliente. Mesmo com orçamento mais apertado,

vinibilhar@grupoahora.net.br Indicadores
Dólar: R$ 5,40
Ibovespa: 143.398,63
ele busca pequenos prazeres. E os nossos produtos, muitas vezes, entram exatamente nesse espaço de indulgência acessível. O que muda é o comportamento: há uma busca maior por marcas confiáveis e bom custo-benefício. Por isso, temos trabalhado para oferecer variedade, diferentes faixas de preço e manter a qualidade que nos diferencia.
Como a infraestrutura regional impacta diretamente a operação e sua capacidade de expansão?
Weiand - A infraestrutura é um fator chave para qualquer indústria, e no nosso caso, que lidamos com alto volume e frequência de entregas, ainda mais. Boas estradas, energia estável e logística eficiente são fundamentais para transformar investimento em produtividade. Nossos Centros de Distribuição, em Lajeado, Pernambuco e agora em São Paulo, são parte dessa estratégia: reduzem distâncias, otimizam rotas e aumentam nossa capacidade de resposta. A qualidade da infraes-
trutura não só sustenta o presente, mas define o quanto podemos crescer no futuro.
Como você vê o ano de 2026? Dentro do cenário comercial e econômico.
Weiand - Vamos completar 90 anos, momento que simboliza maturidade e visão de longo prazo. Apesar de um cenário econômico desafiador, com crescimento moderado e consumidor mais exigente, apostamos em eficiência, inovação e expansão no mercado internacional e em nichos de maior valor agregado.
O que será fundamental para manter a empresa em expansão? Weiand - Crescimento sustentável, investindo em inovação e ampliação de mercado. No Brasil, buscamos consolidar a presença com portfólio diversificado; no exterior, expansão na América Latina, América do Norte e Europa. Reforçamos o compromisso com qualidade, tradição e visão de futuro, atuando com responsabilidade e consistência.



Mateus Souza mateus@grupoahora.net.br
Gabriel
Santos gabriel@grupoahora.net.br
LAJEADO
Um acidente a cada 2,4 dias (57 horas). Total de 118 colisões registradas em dez meses e meio. Números que reforçam a necessidade de soluções e medidas para mitigar os riscos para pedestres e motoristas na Benjamin Constant, uma das principais vias da cidade. Foram três mortes registradas neste ano na avenida.
Os dados foram obtidos junto à Guarda Municipal de Trânsito de Lajeado e à Brigada Militar e leva em consideração um trecho de 7,5 quilômetros, desde o entroncamento com a rua José Franz, no bairro Conventos, até a esquina com a rua Silva Jardim, na Praça do Chafariz, na área central da cidade.
Neste percurso, conforme as autoridades, se concentram a totalidade das ocorrências, seja de danos materiais e lesões corporais. Somente a Guarda Municipal contabiliza 60 acidentes, o que representa quase 12% dos 505 acidentes registrados em todo o território de Lajeado neste ano. A guarda é responsável por atender casos de danos materiais, enquanto a BM responde por ocorrências com vítimas ou mortes.
O acidente mais recente aconteceu na noite de quinta-feira. Por volta das 18h, um engavetamento no cruzamento com a rua Ruy Moraes de Azambuja, no bairro Montanha, causou lentidão no trânsito. Apesar do susto, ninguém ficou ferido. No entanto, foi mais um caso que evidenciou os riscos existentes na avenida.
Dezenas de feridos
De acordo com o 22º Batalhão de Polícia Militar (BPM), a Benjamin Constant teve 58 ocorrências atendidas pela corporação em 2025, até o dia 11 de outubro. En-
TRÂNSITO PERIGOSO
Avenida Benjamin registra um acidente a cada 2,4 dias em 2025
Foram 118 ocorrências relacionadas a colisões na via neste ano, com base em dados da Guarda Municipal de Trânsito e Brigada Militar.
Governo busca avançar na instalação de lombadas eletrônicas
tre elas, dois acidentes com óbito (três mortes) e 37 com vítimas lesionadas (pessoas que sofreram fraturas ou ferimentos e precisaram de atendimento médico).
Outros 18 casos foram registrados como acidentes com danos materiais. Há ainda um registro em que um motorista fugiu do local após a ocorrência. Os bairros Florestal, Centro e Montanha registram a maior parte das ocorrências.
Lombadas eletrônicas
No trecho considerado mais crítico da Benjamin, entre os bairros Bom Pastor e Conventos, o governo municipal avalia a instalação de lombadas eletrônicas na avenida. Um estudo técnico preliminar está em fase de finalização, segundo o secretário municipal de Planejamento, Urbanismo e Mobilidade, Alex Schmitt. Esse material vai nortear a instalação dos equipamentos.
No entanto, o processo tem demorado mais do que o esperado. “A equipe que está preparando os documentos para a licitação está com dificuldade de retorno dos orçamentos. As empresas que foram localizadas não estão respondendo ao nosso contato. Esse tem sido o entrave no andamento desse assunto. Estamos buscando alternativas legais para precificar os serviços”, frisa.


OS BAIRROS COM
MAIS ACIDENTES NA
BENJAMIN CONSTANT
(Com base nos dados da Brigada Militar)
Florestal – 17
Centro – 16
Montanha – 9
Conventos – 6
Moinhos d’Água – 4
Bom Pastor – 3
Jardim Botânico – 3
LEVANTAMENTO
DETALHADO – 2025
ACIDENTES NA BENJAMIN CONSTANT
Trecho monitorado: entre a Rua José Franz (bairro Conventos) e a Rua Silva
Jardim (Praça do Chafariz) – extensão aproximada de 7,5 quilômetros
DADOS DA BRIGADA MILITAR 22º BPM ATÉ 11 DE OUTUBRO
– 58 ocorrências registradas
– 37 com vítimas lesionadas
– 18 com danos materiais
– 2 com óbito (três mortes)
– 1 caso de fuga do local
DADOS DA GUARDA MUNICIPAL DE TRÂNSITO GMT ATÉ 16 DE OUTUBRO
– 60 acidentes registrados
– Todos com danos materiais
– Representam 12% dos 505 acidentes registrados em todo o município

A equipe que está preparando os documentos para a licitação está com dificuldade de retorno dos orçamentos. As empresas que foram localizadas não estão respondendo ao nosso contato. Esse tem sido o entrave no andamento desse assunto [lombadas eletrônicas na Benjamin]”
Acidentes se tornaram corriqueiros na principal avenida de Lajeado

Morte de jovens reacende debate sobre controladores








DEBATE SOBRE CONTROLADORES
– Em julho, reportagem especial do A Hora detalhou os desafios, o histórico recente de acidentes e os planos para o futuro da avenida Benjamin Constant;
– A matéria foi produzida dois dias após um acidente que matou duas pessoas, na altura do bairro Bom Pastor, e que comoveu a comunidade local.





ESTUDO DAS REGIÕES
Destaque na economia e deficiência na infraestrutura
Diagnóstico do Estado aponta potenciais e carências do Vale. Documento mostra necessidade de investir em saneamento, urbanização e resiliência para mitigar prejuízos das tragédias climáticas
Produto Interno Bruto (PIB) acima dos R$ 19 bilhões, oitava maior economia do Rio Grande do Sul, com crescimento médio anual de 0,82%. Tais aspectos positivos do Vale do Taquari contrastam com deficiências estruturais em saneamento, envelhecimento populacional e vulnerabilidade diante de riscos ambientais.
Apenas 8,6% da população tem acesso à rede de esgoto (contra 42,7% no Estado), e 20% dos habitantes foram atingidos de forma direta pelas inundações de 2023 e 2024.
Nos potenciais e carências da região, o Perfil Socioeconômico do Vale do Taquari traz um retrato detalhado das condições locais e da capacidade de reação das

O estudo é a base oficial usada pelo Estado e pelos Coredes. Ele mostra com clareza onde estão os gargalos e onde é possível avançar.”
comunidades após os desastres. Neste diagnóstico, avalia a presidente do Conselho de Desenvolvimento (Codevat), Cintia Agostini, existe uma confirmação
da importância econômica do Vale: a indústria e o setor de serviços respondem por mais de 70% do Valor Adicionado Bruto (VAB), com forte presença nos segmentos alimentício e calçadista.
Esse desempenho é sustentado por um ecossistema de pequenas e médias empresas que garantem estabilidade e emprego, mas que também expõem a dependência de cadeias tradicionais e pouco diversificadas. Em cenários de retração de consumo ou interrupções logísticas, a vulnerabilidade é imediata.
Na avaliação da presidente do Codevat, a atualização dos perfis regionais é indispensável para reduzir distorções e orientar decisões com base em evidências. “O estudo é a base oficial usada pelo Estado e pelos Coredes. Ele mostra com clareza onde estão os gargalos e onde é possível avançar. O saneamento e o envelhecimento populacional são os grandes alertas, e exigem políticas conjuntas”, afirma.
O levantamento, feito pelo Departamento de Planejamento Governamental (Deplan) da SPGG, atualiza a versão de 2015 e integra a edição 26 da Revista Estudos de Planejamento, publicação que norteia o redesenho das políticas públicas regionais.


Desempenho dos serviços e da indústria faz com que a economia local seja uma das mais desenvolvidas do RS. O somatório de 36 municípios do Vale fazem com que o Codevat esteja na 8ª posição entre 27 regiões
Avanço em renda e saúde, queda na educação
Com base no Índice de Desenvolvimento Social e Econômico (Idese), o Vale está entre as regiões entre médio e alto desenvolvimento, na sétima posição entre os 27 Coredes. Os destaques ficam no bloco Saúde (0,884, 3º lugar estadual) e para Renda (0,811, 7º lugar).
Já a Educação perdeu vantagem em relação à média gaúcha (no Estado, com Idese de 0,739, ante 0,73,7 do Vale).
Outro contraste é a desigualdade econômica. Lajeado concentra quase um terço do PIB regional, enquanto municípios menores enfrentam estagnação ou perda populacional. O envelhecimento avança em ritmo superior à média estadual, elevando custos com saúde e reduzindo a base ativa do mercado de trabalho. “Há ilhas de prosperidade cercadas por fragilidades. O desafio é garantir equilíbrio territorial”, resume Cíntia.
Enchentes e reconstrução
O estudo dedica um capítulo específico às consequências
do desastre de 2024. O Vale do Taquari aparece como epicentro do desastre no RS.
Seis dos dez municípios com mais atingidos gaúchos estão na região. Muçum, Roca Sales, Travesseiro, Colinas, Arroio do Meio e Marques de Souza tiveram entre 45% e 79% da população afetada.
Na infraestrutura viária, houve danos em 1,5 mil quilômetros de estradas, 103 escolas e 34 unidades de saúde.
• 1.503 KM DE MALHA VIÁRIA (16,1% do total).
• 103 ESCOLAS E 34 EQUIPAMENTOS DE SAÚDE (27 UBSs + 7 hospitais).
• PORTO DE ESTRELA E TRECHOS DA FERROVIA Roca Sales–Vacaria/Passo Fundo danificados.
INFRAESTRUTURA AFETADA INICIATIVAS PROMISSORAS
• BIOMASSA: 4ª região em produção residual (destaque para Estrela)
• REATIVAÇÃO LOGÍSTICA: potencial para hidrovia do Rio Taquari (Eclusa de Bom Retiro no Novo PAC).
• RECURSOS HÍDRICOS: 27 municípios com alto oumáximo Índice de Segurança Hídrica (ISH-U).


Pelo diagnóstico, uma das principais estratégias públicas precisa ser concentrada em obras de contenção, drenagem e
saneamento básico.
Para a SPGG, o diagnóstico reforça a urgência de adotar políticas de mitigação e de
resiliência territorial. A secretária Danielle Calazans afirma que o documento servirá como guia para definir investimentos do Plano Rio Grande e para a captação de recursos externos.
“O levantamento oferece uma leitura territorializada da reconstrução. Cada região precisa ser compreendida na sua particularidade. Planejar com base em dados é o primeiro passo para reduzir desigualdades e prevenir tragédias”, destaca.
Oportunidades
Além do diagnóstico econômico e social, o perfil lista “iniciativas promissoras” e “questões que merecem atenção especial”. Entre as oportunidades estão a geração de energia a partir de biomassa (o Vale é o quarto maior produtor do Estado) e a reativação da hidrovia do Rio Taquari, cuja eclusa de Bom Retiro do Sul
tratamento de esgoto colocam a região entre as piores no saneamento
integra o Novo PAC. Também aparecem a ampliação da infraestrutura de abastecimento e a diversificação industrial em cadeias de maior valor agregado.
Alerta vermelho
Como pontos críticos, a região está entre os menores índices no saneamento básico do RS. A coleta seletiva é quase nula, a qualidade da água comprometida por fósforo e coliformes fecais, e existe áreas de apagão em termos de telefonia e internet em áreas rurais.
Pela conclusão do estudo, o desenvolvimento regional depende de políticas integradas para além de crescimento econômico, com programas específicos no tratamento do esgoto, recolhimento de lixo,
DO VALE
(Os dados se referem a 36 municípios integrantes do Codevat)
• POPULAÇÃO: 361.273 habitantes
• CRESCIMENTO MÉDIO (2010–2022): 0,82% ao ano (3ª maior do RS)
• PIB REGIONAL: R$ 19,1 bilhões (8ª maior economia gaúcha)
• URBANIZAÇÃO: 79,4% (RS: 87,5%)
• SANEAMENTO: 8,6% da população atendida (RS: 42,7%)
• PESSOAS ATINGIDAS PELAS CHEIAS DE 2024: 73.291 (20% da população)
• MUNICÍPIOS MAIS AFETADOS: Muçum, Roca Sales, Travesseiro, Colinas, Arroio do Meio e Marques de Souza
uso de energias renováveis e resiliência climática.
“Esses dados precisam ser transformados em ações regionais. O perfil é o ponto de partida. Cabe aos conselhos, municípios e Estado traduzirem os números em projetos que façam diferença.”

NOVOS ROTEIROS
Na natureza, a aposta ao crescimento do turismo

Região sedia o Seminário Estadual de Turismo de Natureza e o 3º Simpósio Gaúcho de Trilhas de Longo Percurso entre os dias 18 e 22 de outubro. Rota religiosa Caminho de Lourdes, com mais de 250 quilômetros e passagem por 16 cidades do Vale, será lançada durante o evento
Karine Pinheiro karine@grupoahora.net.br
VALE DO TAQUARI
No Vale do Taquari, a oportunidade de desenvolver um setor em amplo crescimento no mundo. As belezas naturais da região ganham espaço e despontam com potencial de impulsionar e qualificar o ecoturismo. Com essa proposta, Lajeado sedia, entre os dias 18 e 22 de outubro, o Seminário Estadual de Turismo de Natureza e o 3º Simpósio Gaúcho de Trilhas de Longo Percurso, na Univates. A proposta do turismo de natureza como alternativa de desenvolvimento econômico e social avança como prioridade estratégica no Rio Grande do Sul.

Uma simples área de contemplação da natureza tem potencial de virar produto turístico”
região amplia a capacidade de transformar turismo em negócios. Secretária-executiva da Associação dos Municípios de Turismo do Vale do Taquari (Amturvales) e presidente da Associação Brasileira de Turismólogos e Profissionais de Turismo (ABBTUR-RS), Vanessa Spindler destaca as possibilidades de gerar sustentabilidade, emprego e renda ao qualificar o segmento.
Segundo a Secretaria de Turismo, o segmento possui projeções que ultrapassam US$ 2 trilhões até 2032. O objetivo da pasta é consolidar o setor como pilar de desenvolvimento regional ao movimentar diversas esferas. O evento reúne representantes do Poder Público, iniciativa privada e entidades do setor para debater políticas, qualificação e novos roteiros regionais. A programação conta com painéis, grupos de discussão, atividades técnicas e o pré-lançamento do roteiro Caminho de Lourdes. A rota religiosa, com mais de 250 quilômetros, conecta 16 municípios do Vale.
Ao sediar o seminário, a
“Fomos uma região muito afetada pelas catástrofes climáticas, mas ainda temos um potencial enorme em preservar o meio ambiente. O Vale tem muitos produtos de ecoturismo, que ainda precisam ser melhorados, mas que se tornam viáveis com uma estrutura adequada. Como exemplo na região, o Perau do Facão, que demonstra essa potencialidade”, afirma Vanessa.
Identificar potencialidades
Gerente técnico da Associação Brasileira das Empresas de Ecoturismo e Turismo de Aventura (Abeta), Evandro Schütz diz que a geografia do estado é propícia para consolidar produtos existentes e criar novas oportunidades. Ele esclarece que turismo de natureza possui diversos segmentos, não apenas
A gruta em honra a Nossa Senhora de Lourdes possui uma das maiores cavernas de basalto da América Latina. Tem 30 metros de largura e 112 metros de comprimento. O ambiente interno é iluminado. Junto da gruta, está o espaço com bancos para celebrações religiosas.


O ponto turístico sedia a tradicional festa em honra a santa. Possui boa estrutura com salão coberto e churrasqueiras. Gruta une religiosidade e beleza natural, com imagem da santa colocada em meio aos paredões.



Localizada a 10 km do centro da cidade, é um destino de charme natural e devoção. A imagem da santa repousa numa cavidade rochosa ao lado de uma pequena queda de água que se forma em épocas de chuvas mais constantes. A gruta de Campo Branco sedia uma grande festa em fevereiro.
atividades radicais.
“Além da aventura, temos muitos pontos com água, algo que chama a atenção de turistas. O estado possui estações bem definidas, o que também auxilia na elaboração de roteiros por temporadas. Uma simples área de contemplação da natureza tem potencial de virar produto turístico se bem observado”, salienta o gerente. Segundo Schütz, a região possui roteiros e infraestruturas consolidadas. No vale, são mais de 160 meios de hospedagem, centenas de restaurantes e uma série de rotas temáticas, como Caminhos das Cascatas e Delícias da Colônia. Para firmar o turismo
de natureza como atividade permanente, na avaliação dele, é necessário garantir a viabilidade financeira e capacitação.
Qualificação
A secretária-executiva da Amturvales aponta a qualificação do setor como caminho para promover a sustentabilidade do ecoturismo e a viabilidade financeira. “É necessário se organizar como região e pensar a profissionalização. É possível gerar emprego, fazer melhorias em propriedades e alavancar atividades rurais e radicias”, frisa. Para o jornalista Fábio Kuhn, idealizador do portal 365 Vezes




Cascata possui mais de 70 metros que forma um véu no local. Estrutura com altar improvisado na cavidade rochosa, onde ocorre eventos, como a tradicional festa em honra a Nossa Senhora de Lourdes. Uma escadaria com 174 degraus leva até o interior da gruta.

Possui cascata com cerca de 36 metros localizada próximo da Gruta Nossa Senhora de Lourdes. Uma placa próxima da estrada sinaliza o início da trilha até o ponto, que se trata de uma caminhada de aproximadamente dois quilômetros que cruza o riacho.

FÁBIO KUHN

Pode parecer algo simples de se fazer, mas tem que ter equipamento adequado, conhecer a região, melhorar estruturas e investimento financeiro”
Caminho de Lourdes
União de turismo e religiosidade, o Caminho de Lourdes surge como aposta de ecoturismo ao conectar 16 cidades na região. A iniciativa, idealizada por Alício de Assunção, passa a fazer parte da Rede Nacional de Trilhas. Ao todo, são 250 quilômetros que passam por grutas que homenageiam Nossa Senhora de Lourdes.
O trajeto, segundo ele, será autoguiado. A expectativa que é a infraestrutura da rota, como a sinalização, esteja concluída até maio de 2026. Ele também destaca a participação de centenas de propriedades ao longo do caminho que devem se beneficiar da implantação do roteiro, como objetivo de impulsionar o turismo rural.
no Vale, trazer o seminário para o Vale do Taquari é uma forma de provocar para o tema e reascender a discussão sobre a exploração do potencial. Na avaliação dele, existe a necessidade de investir em guiamento, acessos a empreendimentos e sinalização. “É preciso fornecer informações e segurança. Qualificar guias é uma forma de atrair pessoas que querem estar em meio à natureza, mas têm receio por não conhecer os locais. Pode parecer algo simples de se fazer, mas tem que ter equipamento adequado, conhecer a região, melhorar estruturas e investimento financeiro”, avalia Kuhn.
VANESSA SPINDLER SECRETÁRIA-EXECUTIVA
É possível gerar emprego, fazer melhorias em propriedades e alavancar atividades rurais”, Vanessa Spindler” Turismo sustentável
Depois de vinte anos, o Estado retoma o Seminário Estadual de Turismo de Natureza, um dos primeiros fóruns brasileiros voltados ao turismo ao ar livre. O evento marca a volta de um espaço de debate e capacitação que, após duas décadas de pausa, retorna em um novo contexto para promover um turismo mais sustentável, integrado e inovador.
A organização é da Amturvales, ABBTUR/RS e Abeta, com patrocínio da Secretaria de Turismo (Setur) e apoio da Secretaria do Meio Ambiente e Infraestrutura (Sema).A iniciativa simboliza o reencontro entre o Poder Público, a iniciativa privada e o meio acadêmico.

Turismo de natureza no Vale
Cascata Três Quedas
Com camping e trilha para acessar a cachoeira, ponto turístico natural fica localizado em Vespasiano Corrêa, nas proximidades do Viaduto 13.
Recanto Cascata V13
Também localizado em Vespasiano Corrêa, espaço oferece trilhas com destino à cascata e guiamento pela Ferrovia do Trigo. Possui estrutura com hospedagem em cabanas e alimentação. Posicionado ao lado do maior viaduto da América.
Cascata Jardim
das Deusas
Destaque durante os verões de 2024 e 2025, a Cascata Jardim das Deusas fica localizada em Pouso Novo. O espaço, de 55 hectares, possui trilha e uma cachoeira com cerca de 30 metros, cercada por paredões de água cristalina.
Cascata Bombinha
Localizada em Muçum, o principal atrativo é a Cascata Bombinha, com salto d’água de 40 metros de altura. Possui outras pequenas quedas d’águas e uma antiga barragem. Para acessar as cascatas é necessário fazer trilha de aproximadamente dois quilômetros em trajeto bem sinalizado. Conta com estrutura de camping e pousada em pipas de vinho.
Perau do Facão
Considerada a cascata mais bonita do RS, o Perau do Facão, em Arvorezinha, possui 80 metros de altura. O acesso é feito por uma passarela de 250 metros, adaptada para cadeirantes. A beleza natural se diferencia pelas quedas d’água que se dividem em um poço. Possui infraestrutura para acampamento. Recentemente foi implantado sky bike e tirolesa.
Sobre o Caminho de Lourdes
Roteiro turístico e religioso, com passagem por 16 municípios do Vale do Taquari
Percurso com mais de 250 quilômetros
Rota dedicada a Nossa Senhora de Lourdes
Conecta quedas d’água, cavernas e formações rochosas
Percurso pode ser feito a pé, de bicicleta ou motocicleta
CONSTRUÇÃO CIVIL
Mercado imobiliário regional vai na contramão do país
Enquanto há retração nas capitais e regiões metropolitanas, estudo do Sinduscom-VT revela que no Vale há quatro vezes mais empreendimentos no semestre. Setor cresce com demanda, mas esbarra nos juros e na necessidade de previsibilidade sobre rumos da economia
VALE DO TAQUARI
Ociclo mais recente da construção civil combina velocidade de lançamentos, mudança no perfil dos produtos e necessidade de planejamento fino. É o que mostra o Panorama do Mercado Imobiliário no Vale do Taquari, estudo inédito apresentado pelo Sinduscom-VT em parceria com a Brain Inteligência Estratégica e com a Federação das Indústrias do RS (Fiergs). No primeiro semestre deste ano, o número de empreendimentos verticais lançados foi quatro vezes maior que no mesmo período do ano passado, com Lajeado concentrando mais de 90% das novas unidades. Em 12 meses, o Valor Geral de Vendas (VGV) lançado no município cresceu 72%.
Para o presidente do
Resumo dos resultados
I. Mercado Vertical em Lajeado e Vale do Taquari
Contexto:
As cidades analisadas representam 1,8% da população total do RS e 2,1% do potencial de consumo estadual.
Crescimento:
O número de empreendimentos verticais lançados foi quatro vezes maior no 1º semestre de 2025 em relação ao mesmo período de 2024. Lajeado concentrou mais de 90% das novas unidades.
VGV (Valor Geral de Vendas): Em 12 meses (jun/24 × jun/25), o VGV lançado em Lajeado cresceu 72%, impulsionado por novos produtos e pela retomada do alto padrão.
Sinduscom-VT, Daniel Bergesch, o levantamento tira o setor da intuição e coloca a decisão em cima de evidências. “Precisamos de um norte. Entre projeto e entrega passam três, quatro, cinco anos. Nesse tempo, juros, crédito e política mudam mais de uma vez. Sem dados consistentes, todo investimento vira palpite.” Essa constatação se aproxima da avaliação do consultor da Brain, Hamilton Leite. Ao comparar o Vale com outras localidades pesquisadas no RS, aponta como diferencial o combo entre demanda e resposta das construtoras.
Mudança de perfil
A fotografia atual reúne volume e também mudanças no perfil dos produtos. Conforme o relatório, entre 2020 e 2022, o padrão médio dominou o mercado. A partir de 2023, duas frentes ganharam espaço: Minha Casa Minha Vida e compactos.
Tendências nacional
Ritmo de mercado: Apesar da retração em capitais e regiões metropolitanas, o Vale do Taquari segue na contramão, com desempenho acima da média nacional.
O VGV acumulado em 12 meses no país teve alta de +9,6%, mas o número de lançamentos caiu, enquanto as vendas cresceram.
Estoque: A oferta no país caiu 4,1%. Mantido o ritmo atual, o estoque nacional se esgotaria em 8 meses sem novos lançamentos.
Participação do MCMV: O programa responde por 46% das 102.896 unidades vendidas no segundo trimestre de 2025.

Até junho deste ano, o MCMV respondeu por 36% das unidades verticais lançadas e os compactos por 29%. O alto padrão, ausente nos anos anteriores, voltou a aparecer e já soma 12% das novas unidades.
Imóveis de dois dormitórios lideram, com 67% das ofertas, seguidos pelos três dormitórios (17%).
Sobre essa demanda, o estudo do Sinduscom capta um
Intenção e per l
Geração Z: A intenção de compra da faixa 21–28 anos cresceu cerca de 1/3 em 12 meses.
Imóvel desejado: O apartamento é o mais procurado (49% no total; 64% entre renda até R$ 5 mil).
Faixa de Preço: 71% das aquisições até R$ 400 mil, maioria via programas de habitação.
Motivação de Compra: Sair do aluguel (33%) Trocar por imóvel maior (21%)
movimento etário. A Geração Z (21 a 28 anos) ampliou em quase um terço a intenção de compra em 12 meses. Em todas as rendas, o apartamento é o imóvel mais desejado (49% no total, 64% para renda até R$ 5 mil).
Sete em cada dez aquisições ocorrem até R$ 400 mil, e o motivo mais citado para comprar segue sendo sair do aluguel.
Visão do mercado
Qualidade de vida, localização geográfica, qualidade dos empreendimentos e acesso a serviços públicos. A combinação
Crédito e custo do dinheiro
No Vale
Inadimplência: Baixíssima, em 1,4% (junho/2025).
Descompasso no nanciamento: A captação bancária (funding) caiu 52% no acumulado de sete meses.
Poupança Recursos para aquisição via SBPE recuaram de R$ 12,6 bi para R$ 10,6 bi em 12 meses.
Sustentação via FGTS: O FGTS passa a responder por 20% mais funding, tornandose o principal motor do crédito habitacional.
desses fatores faz com que haja muita procura por empreendimentos imobiliários, avalia o diretor da Diamond, Gustavo Schmidt. “O Vale virou destino de moradia e investimento. A verticalização aproxima as pessoas dos serviços e devolve o tempo. Hoje, tempo é um dos maiores luxos.”
Para ele, o Vale do Taquari está no mapa das regiões mais competitivas. “Não ficamos atrás de nenhuma cidade gaúcha em termos de qualidade construtiva e variedade de lançamentos. Há um padrão técnico e estético consolidado, que acompanha o que se vê nas capitais.”
Schmidt reconhece que o crédito caro e escasso no mercado exige cuidado, mas enxerga o momento como oportunidade. “Quem se posiciona agora, vai colher bons resultados quando a



curva de juros cair. O investidor que entra neste ciclo tende a capturar valorização nos próximos lançamentos.”

Diagnóstico foi apresentado em evento do Sinduscom-VT
Cenário nacional
Se a ponta comercial está em uma curva ascendente, a financeira exige cautela. A inadimplência do crédito imobiliário segue baixa (1,4% em junho de 2025), mas a captação de recursos em instituições bancárias (funding) teve queda de 52% no período de sete meses.
O Sistema de Poupança e Empréstimo (SBPE) desacelerou (de R$ 12,6 bi para R$ 10,6 bi em um ano), e o FGTS é quem sustenta essa base, com previsão de crescimento de 20% no ano.
“O maior gargalo é o custo do dinheiro. Os bancos públicos concentram o crédito. Alternativas privadas existem, mas ainda são caras”, resume o presidente do Sinduscom.
O cliente
Neste contexto, a estratégia passa por precisão de produto e execução. Para o diretor da Dohka Empreendimentos, Mateus Pedó, a leitura do mercado nasce no chão de loja. “Estar próximo do time de vendas encurta a curva de erro. É ali que a gente percebe quando um estúdio vira dois dormitórios, quando uma varanda gourmet troca de lugar. Quem acerta projeto e entrega bem.”
Sobre o aumento de lançamentos, avalia que demanda reprimida, valorização da cidade e postura das construtoras caminham juntas. “Só não vende quando o preço é acima do que vale. Quando é justo, vende. Nossa região tem bons índices e um empreendedorismo forte.”
ENTREVISTA
JONI ZAGONEL,
presidente da Acil e diretor da Construtora Zagonel
“Lajeado vive um momento positivo”
A Hora — O estudo reforça o protagonismo de Lajeado no mercado imobiliário regional. Que fatores você identifica como determinantes para essa expansão?

Joni Zagonel — Lajeado vive um momento muito positivo, resultado da soma de vários fatores. Mesmo com muito a melhorar, temos uma infraestrutura urbana de qualidade, boa rede de serviços e um ambiente de negócios estável. A confiança do investidor e o diálogo entre setor produtivo e gestão pública fortalecem esse movimento. O consumidor percebe esse crescimento e acredita que a região seguirá atrativa, o que estimula novos investimentos.
— O perfil de quem compra mudou após a pandemia e a reconstrução da região?
Zagonel — Mudou bastante. O comprador busca funcionalidade,
conforto e tecnologia. Quer morar bem, em espaços mais inteligentes, com eficiência energética e boas áreas de convivência. Os imóveis compactos e bem localizados ganharam força, e o investidor regional está mais ativo, vendo o imóvel em Lajeado como uma aplicação segura e com potencial de valorização.
— De que forma esse crescimento da construção civil impacta a economia local? Zagonel — A construção civil tem papel central. Cada obra movimenta dezenas de setores e gera empregos, renda e arrecadação. É um efeito multiplicador. Para manter o ritmo, precisamos reduzir a burocracia e tornar o emprego formal mais acessível. Quando o custo de contratar cai e o rendimento aumenta, todos ganham: empresas, trabalhadores e o próprio município. Esse é o caminho para crescer com equilíbrio.

Grupo paulista projeta investimento de R$ 40 milhões em condomínio logístico


Investidores projetam a geração de 2,5 mil empregos diretos até a maturação do complexo. Terreno foi planejado para ficar 10 metros acima da cota de inundação
Gabriel Santos gabriel@grupoahora.net.br
MARQUES DE SOUZA
Um grupo de investidores de São Paulo apresentou nessa quinta-feira, 16, em Marques de Souza, os detalhes do projeto de construção do condomínio logístico e industrial Vogar
Terras Altas, que será implantado às margens da BR-386, no quilômetro 331, em Linha Perau. O evento contou com a presença de líderes empresariais, vereadores e integrantes do alto escalão do governo municipal.
A apresentação foi conduzida pelo sócio-diretor da Vogar Empreendimentos, Cláudio Borges Abate Júnior, que destacou o potencial econômico da região do Vale do Taquari e o apoio do município como fatores decisivos para a escolha do local.
“Encontramos boas condições em Marques de Souza. Logística
favorável, PIB elevado e um bom suporte no abastecimento de energia de alta-tensão”, afirmou. A área de 40 hectares foi adquirida pela empresa paulista da família de Hernani e Cristiano Scherer e deve abrigar 80 lotes industriais, com tamanhos variando entre 500 e 3 mil metros quadrados.
O terreno foi planejado para ficar 10 metros acima da cota de inundação, garantindo segurança contra cheias. O investimento estimado para o complexo é de R$ 35 a R$ 40 milhões, contemplando a abertura de ruas, infraestrutura de acesso, drenagem e rede elétrica. A expectativa é de geração de até 2,5 mil empregos diretos entre a fase de construção e a consolidação do empreendimento.
Alteração no zoneamento
Atualmente, o projeto está em análise ambiental e depende de alteração no zoneamento, já que o terreno está em área rural. A previsão é de que as obras tenham início no segundo trimestre de 2026, após a conclusão dos trâmites legais.
Segundo Abate Júnior, o Vogar Terras Altas nasce com a proposta de atrair novas empresas e fortalecer a base industrial regional. “Teremos um espaço adequado para atrair as empresas. Temos certeza que vamos posicionar Marques de Souza como um novo polo logístico no Vale do Taquari”.
Encontramos boas condições em Marques de Souza. Logística favorável, PIB elevado e um bom suporte no abastecimento de energia de alta tensão”
CLÁUDIO BORGES ABATE JÚNIOR SÓCIO-DIRETOR DA VOGAR EMPREENDIMENTOS
Ciclo de desenvolvimento
Para ovice-prefeito Lairton Heineck, é uma honra para Marques de Souza ser o palco deste anúncio. Cita que é “o projeto certo na hora certa”, com potencial para gerar emprego e renda e potencializar novos investimentos no município.
“A BR-386 é a estrada da produção e nossa terra é de oportunidades. Esse projeto vai trazer resultados de curto, médio e longo prazo. Daremos todo o apoio, junto da câmara de vereadores. Estamos orgulhosos dessa conquista, que se soma ao ciclo de desenvolvimento que vivemos nos últimos anos”, afirma.

FAMÍLIAS À ESPERA
Demora na entrega de casas leva deputados a Estrela
Em seminário na Câmara de Vereadores, parlamentares afirmaram que acompanharão de perto cada contrato habitacional e intensificarão a cobrança por prazos e entregas. Estrela projeta investir R$ 7,32 milhões em aluguel social entre 2025 e 2027, enquanto aguarda a conclusão de novas moradias
ESTRELA
Alentidão na entrega de moradias para famílias atingidas pelas enchentes voltou ao centro do debate nessa sexta-feira, 17, em Estrela. O município sediou o seminário Unidos pela Reconstrução do Rio Grande do Sul – Vale do Taquari e Alto Taquari, promovido pela Comissão Externa da Câmara dos Deputados.
O encontro reuniu autoridades municipais, estaduais e federais, além de lideranças comunitárias e representantes de diversos setores, com foco principal na habitação.
Habitação no foco
O relator da comissão,

deputado Pompeo de Mattos (PDT), reforçou que a moradia é hoje o tema mais urgente. “Precisamos jogar luz sobre esse processo e cobrar agilidade dos governos. Em Estrela, por exemplo, há previsão de até 1,6 mil moradias federais, mas menos de cem estão em andamento. A comissão está aqui para fiscalizar e pressionar. O que está no papel precisa sair do papel”, afirmou.
O coordenador da comissão, Marcel van Hattem (NOVO), destacou que “de cada cinco casas prometidas, apenas uma foi
entregue” no estado.
Segundo ele, os prazos já foram ultrapassados e a fiscalização será constante. “Vamos acompanhar contrato por contrato, fazer um pente-fino e cobrar cada etapa. Não podemos admitir novas enrolações. As famílias precisam recuperar sua dignidade e o Vale precisa acelerar sua reconstrução.”
Números
O panorama apresentado pelo município revela que, apesar do
avanço de alguns programas, a moradia ainda está longe do ideal. Estrela soma mais de 1.300 casas anunciadas pelo governo federal entre compra assistida e novas construções, mas nenhuma unidade concluída foi entregue até agora. Pelo Estado, são 108 moradias previstas, cerca de 20 perto da conclusão e o restante ainda em fase de infraestrutura de terrenos. Outro dado que chama atenção é o investimento projetado em aluguel social: R$ 7,32 milhões entre 2025 e 2027.
O valor seria suficiente para construir mais de 36 casas, considerando o custo médio de R$ 200 mil por unidade.
Compromisso local
A prefeita Carine Schwingel apresentou aos deputados um diagnóstico completo dos principais entraves e cobrou celeridade.
“As pessoas precisam e merecem essas casas. Estamos pedindo a aceleração da parte burocrática e da liberação de recursos. Nosso objetivo é entregar as moradias o quanto antes”, afirmou.
Carine também destacou as ações já executadas com apoio dos governos federal e estadual, como compra assistida, projetos de infraestrutura e reconstrução de espaços públicos. “O seminário serviu para mostrar onde estão os gargalos e reforçar que a habitação precisa ser prioridade absoluta.”
Próximos
passo
Representando o governo federal, o secretário de Apoio à Reconstrução, Maneco Hassen, defendeu que o ritmo precisa melhorar. “São mais de R$ 110 bilhões aplicados no Estado. Já temos cerca de 400 famílias em novas casas e mais de 100 moradias em construção. Em breve, 800 novas unidades devem ter obras iniciadas”, disse. Ele também citou a meta de alcançar a média de “uma casa por dia” entregue na região.
O compromisso dos deputados é seguir cobrando agilidade e transparência. “Não vamos parar enquanto cada promessa não sair do papel”, garantiu Pompeo de Mattos.

Programação natalina aproxima comunidade do Rio Taquari

LAJEADO
SEvento promovido pela administração municipal será pela primeira vez no Parque Ney Santos Arruda, espaço construído em 2023 e reestruturado após a enchente histórica de 2024
Mateus Souza
mateus@grupoahora.net.br
Eloisa Silva eloisasilva@grupoahora.net.br
ímbolo da reaproximação da comunidade com o Taquari, o Parque Ney Santos Arruda será palco, neste ano, do evento natalino de Lajeado. O Natal no Coração 2025, que inicia em novembro, terá suas principais atrações na área de lazer às margens do rio, projetada ainda na década passada e inaugurada em 2023. A programação oficial será divulgada nas próximas semanas.
A mudança de local – nos últimos anos, a programação ocorreu no Parque dos Dick – havia sido anunciada em primeira mão pela presidente da Câmara de Dirigentes Lojistas (CDL), Giselda Hahn, em entrevista à Rádio A Hora na quarta-feira, 15. Na sexta-feira, foi oficializada pela Secretaria Municipal de Cultura, Esporte, Lazer e Turismo. Reconectar a população com o
rio, conforme o secretário Carlos Reckziegel, é o principal argumento para a ida do evento de fim de ano para o parque. “O evento vai nos levar para perto de um dos maiores tesouros da nossa cidade e região. Serão dias encantadores para celebrar o Natal perto do rio. Teremos um ambiente muito acolhedor para receber as famílias”, garante.
A programação inicia no dia 21 de novembro e se estenderá até 23 de dezembro, e contará com a Aldeia do Noel, oficinas culturais para estudantes do município, a ação “Adote uma Árvore de Natal”, realizada por entidades sem fins lucrativos e empresas, renas decoradas, feira de artesanato e ervateira.
Cultura e passeios
A programação do Natal no Coração terá mais de 40 atrações musicais e vai contemplar orques-
tras, bandas, grupos de danças, DJs e um show nacional, que será anunciado nos próximos dias. Além disso, com a ida para as margens do Taquari, a expectativa é de que o evento inclua também atividades náuticas para fortalecer o turismo e a economia local.
Outro destaque é o retorno do Cedelinho, o tradicional ônibus natalino de dois andares, em parceria com a CDL Lajeado. No ano passado, foram 1,2 mil passeios e cerca de 15 mil passageiros. Em 2025, os trajetos iniciam em 20 de novembro e seguem até 23 de dezembro, com saída do Parque Ney Santos Arruda.
Lajeado Brilha apresenta novidades
Com uma premiação que ultrapassa os R$ 200 mil, o Lajeado Brilha 2025 foi lançado oficialmente na noite de quinta-feira, 16. A campanha natalina da Câmara de Dirigentes Lojistas (CDL Lajeado) foi apresentada aos diretores da entidade, empresas participantes e autoridades em evento na CarHouse Hyundai, às margens da ERS-
130, no bairro Florestal.
Entre as novidades da edição deste ano da principal campanha voltada ao incentivo às compras no comércio local, está o novo formato de participação, agora totalmente digital. Também será feita a remodelação da identidade visual da promoção.
A campanha Lajeado Brilha 2025 iniciou na sexta-feira, 17, e seguirá até 24 de dezembro. Com sorteio de um Hyundai HB20 Flex Limited zero km e uma Honda Biz 125 zero km, a promoção terá ainda R$ R$ 80 mil em vales-compras de R$ 400 e de R$ 200, além de mil prêmios instantâneos oferecidos pelas empresas participantes.
As empresas participantes também poderão oferecer prêmios extras, integrados ao sistema digital, decidindo se os sorteios ficarão restritos aos próprios clientes ou abertos a toda a campanha. Até o momento, 150 empresas já aderiram ao pacote, mas as inscrições seguem abertas até 31 de outubro. Segundo a presidente da CDL Lajeado, Giselda Hahn, a campanha traz mudanças significativas neste ano. Além de ampliar a premiação, ela será 100% digital, substituindo as tradicionais raspadinhas de papel por um sistema online.
“Contratamos uma empresa de Santa Catarina que atende CDLs de todo o Brasil. A partir de agora, as raspadinhas serão digitais e sustentáveis. O cliente recebe um QRCode na hora da compra, faz um cadastro simples e participa dos sorteios diretamente pelo celular”, explica.




Para a família Friedrich, um colégio com base
Nos anos 1960, Jorge Friedrich ingressou no curso de Técnico de Contabilidade e nunca mais deixou de calcular. Primeiro calculou o próprio futuro, depois o dos filhos, e encontrou nos algarismos a base para a profissão no comércio.
família Friedrich sempre soube o que queria para o futuro. O esforço pessoal de cada um abriu caminho para vestibulares concorridos, formação universitária e trajetórias profissionais sólidas.
O ourives e empresário Jorge Friedrich descobriu no CEAT o gosto pela matemática financeira e, com ela, o valor do trabalho contábil. Foi ali que compreendeu que uma boa base não apenas ensina conteúdos, mas orienta decisões e desperta vocações.
Da aula do técnico em contabilidade ao financeiro do hospital
Nos anos 1960, Jorge Friedrich ingressou no curso de Técnico de Contabilidade e nunca mais deixou de calcular. Primeiro calculou o próprio futuro, depois o dos filhos, e encontrou nos algarismos a base para a profissão no comércio.
“Entrei em 1966. O colégio era forte em matemática. Eu não sabia nada de números. Com o professor Schneidão, aprendi tudo. Ele foi um crânio”, recorda Jorge, que reconhece na base pedagógica do CEAT o alicerce de sua trajetória. Formado em 1968, em uma solenidade no Clube Recreativo, Jorge construiu uma carreira que une o talento de ourives, o olhar empresarial e o voluntariado. Sócio proprietário da Joalheria Hexsel e tesoureiro voluntário há mais de 30 anos do Hospital Bruno Born, transformou o aprendizado escolar em prática cotidiana. Com 60 anos, Jorge prestou

Foi no Ceat que a família compreendeu que uma boa base não somente ensina conteúdos, mas orienta decisões e desperta vocações
vestibular e formou-se bacharel em Direito. As amizades do CEAT resistem ao tempo e aos negócios. Jorge acredita que a boa educação também sustenta as relações profissionais. “Além dos amigos, o colégio me legou o apreço pelo respeito e pela cidadania.”
Valores
Valores que ele tratou de perpetuar, matriculando os filhos na mesma escola. “A gente sempre quis oferecer a melhor educação.” A filha Jiovana, focada e determinada, seguiu medicina tornou-se oftalmologista. O filho Júnior herdou o gosto pela música e transformou a paixão em profissão. Os netos trilham o mesmo caminho, empenhados em construir o futuro com as
lições aprendidas no CEAT. “Tudo o que aprendi no curso de Contabilidade eu uso até hoje, na base do meu trabalho como diretor financeiro do HBB.” Ao olhar para trás, Jorge resume em tom de gratidão: “Sou um homem de sorte, tenho dois filhos maravilhosos e três netos lindos.”
Focada em aula, com visão de futuro
Jiovana Friedrich, 53 anos, sempre teve clareza sobre o que queria. Com foco e determinação, seguiu o caminho da medicina, especializou-se em oftalmologia. Nos anos 1980, ingressou no CEAT com o irmão, Júnior. A mais velha dos dois, logo demonstrou disciplina e senso de propósito.
“Eu sempre soube que queria o melhor para mim. E tinha certeza de que o colégio me daria o embasamento científico necessário para o futuro”, recorda. O objetivo era único: passar em Medicina.


Tocamos muito na noite da região. A música representa uma parte muito grande da minha vida”
Júnior Friedrich
Eu tinha certeza de que o colégio me daria o embasamento científico necessário para o futuro”
Jiovana Friedrich
O vestibular concorrido não a intimidou. “Fiz de tudo para conquistar a aprovação e cumpria com tudo o que o colégio exigia”, diz. As disciplinas de humanas eram suas favoritas e ajudaram a sustentar as boas notas. “Nunca precisei de provão”, comenta com orgulho. Em 1991, foi aprovada no vestibular de Medicina da PUC. Cursou seis anos de graduação e dois de especialização em oftalmologia, consolidando

base forte ensina a fazer escolhas conscientes

uma carreira marcada pelo amor à profissão com foco, preparo e visão de futuro. “O colégio tem essa característica de cobrar para vencer. Ele tira a gente da zona de conforto e faz o aluno dar o máximo de si para conquistar a aprovação”, comenta Jiovana.
Os boletins e materiais são cuidadosamente guardados na casa de Jiovana
O primeiro emprego em função do alemão
Foi justamente a habilidade em língua alemã, aprendida no CEAT, que garantiu a Jiovana o primeiro emprego, na Prefeitura de Arroio do Meio. “Eles me contrataram devido ao meu certificado de alemão”, conta.
Depois dessa primeira oportunidade, tudo fluiu com mais naturalidade, e o consultório veio como consequência. Hoje, a filha Lis, de 19 anos, que estudou no CEAT desde o berçário, segue os mesmos passos da mãe. No primeiro ano do curso de Medicina, ela também percorreu todo o caminho do CEAT e carrega as mesmas lições que marcaram

a trajetória da mãe. “Tenho muito orgulho dela. O CEAT cria um ambiente saudável e acolhedor para nossos filhos estudantes.”
Jiovana olha o boletim antigo e sorri: “A escola foi uma segunda casa. Colaborou para a formação do meu caráter e acrescentou amizades que levo até hoje, e que são muito importantes na minha vida.”


O plano deu certo. Começou na percussão e, com o tempo, experimentou outros instrumentos. “A estrutura da sala de música era ótima. Comecei sem saber tocar nada, mas lá havia piano, violão e flauta. E eu aprendi tudo isso ali.”
Tudo o que aprendi no curso de Contabilidade eu uso até hoje, na base do meu trabalho como diretor financeiro do HBB.”
Jorge Friedrich

Da sala de música à vida nos palcos
Jorge Eugênio Friedrich Júnior, 48 anos, entrou no CEAT com a irmã, Jiovana, nos anos 1980. Desde cedo, descobriu ali uma das paixões que o acompanhariam por toda a vida: a música. “Eu queria entrar no conjunto instrumental para poder viajar pelo Brasil”, recorda.
A vivência no conjunto inspirou a criação de uma banda de rock: Franchicos, nascida no colégio. O grupo atravessou gerações e continua ativo até hoje, com Júnior como único integrante original. “Tocamos muito na noite da região. A música representa uma parte muito grande da minha vida”, conta. Formado como Tecnólogo em Radiologia, trabalha no HBB e professor da Univates, Júnior acredita que a arte e a educação sempre caminharam juntas em sua história. “A
música veio agregada à formação que o CEAT me deu. Tudo o que aprendi ali me ajudou a chegar até aqui.”
Os filhos no trilho certo
Hoje, os filhos Erica, de 11 anos, e Henri, de 8, seguem os mesmos passos e estudam no CEAT. Erica começou aos 5 meses e já demonstra o mesmo entusiasmo do pai. “Eu sempre gostei de estudar ciências. Minhas amigas são minhas companheiras de recreio.” Henri, por sua vez, gosta de alemão, de jogar futebol e de música. O pai acredita que o colégio oferece o mesmo ambiente que o formou. “Espero que eles também encontrem ali o poder de chegar aonde quiserem.”

Desafio online revela antes e depois de prédios e casas históricas
Iniciativa do Arquivo Histórico de Lajeado movimenta as redes sociais com uma proposta simples e curiosa: mostrar as transformações de prédios e casas centenárias da cidade

LAJEADO
As publicações revelam como a paisagem urbana, a arquitetura e até o cotidiano dos moradores se transformaram ao longo das décadas. O Quiz Momento Arquivo Histórico é divulgado semanalmente no Instagram da Secretaria de Cultura, Esporte e Lazer (Secel). Primeiro, é postada uma fotografia antiga, e o público é convidado a adivinhar qual é o local e o que existe ali atualmente. A curadoria das imagens é feita pelo historiador Marcos Rogério Kretz, responsável pelo Arquivo Histórico há mais de 20 anos. Com luvas e todo o cuidado que o manuseio exige, ele
seleciona as fotos que irão para o ambiente digital. “Quando separo essas imagens, me transporto para o passado. Revivo episódios, recordo pessoas e lugares que fizeram parte da história de Lajeado”, conta Kretz. O acervo do Arquivo reúne mais de 500 fotografias, que estão sendo digitalizadas para ficarem disponíveis online. O espaço conta com climatização permanente, garantindo a preservação dos documentos, códices e registros fotográficos, todos manuseados com o uso de luvas.
Reavivamento
Para Kretz, as enchentes recentes também deixaram marcas históricas. “O impacto foi grande, especialmente sobre o patrimônio.


Os documentos são manuseados com o uso de luvas
Mas, de certa forma, o desastre reavivou o interesse das pessoas pela memória da cidade. Elas começaram a olhar novamente para os prédios antigos, para as ruas e praças, e lembrar de como tudo era antes”, reflete.
O projeto tem justamente esse propósito: reavivar memórias e incentivar o olhar sobre o passado, como forma de compreender melhor o presente e projetar o futuro.

Marcos, o historiador que decidiu ativar a participação da população
Da Souza Cruz para o McDonald’s
O primeiro desafio trouxe uma viagem ao passado do Bairro Americano, com uma fotografia da década de 1960 que mostrava a antiga Cia. de Cigarros Souza Cruz.
A publicação despertou curiosidade e recebeu dezenas de comentários. Muitos internautas acertaram: o local da imagem é a esquina da Avenida Senador Alberto Pasqualini com a Rua General Mallet, onde hoje funciona o McDonald’s.
Quando separo essas imagens, me transporto para o passado. Revivo episódios, recordo pessoas e lugares que fizeram parte da história de Lajeado.”
MARCOS KREUTZ HISTORIADOR

Mapa reavalia medida e contempla cidades do Vale
DIVULGAÇÃO

Nova portaria inclui Capitão, Fazenda Vilanova e Westfália entre os municípios aptos a renegociar dívidas rurais
Os municípios de Capitão, Fazenda Vilanova, Itapuca e Westfália foram in-
cluídos na nova lista de cidades habilitadas a participar do programa federal de renegociação de dívidas rurais. A atualização, publicada nesta semana pelo Ministério da Agricultura e Pecuária (Mapa), atendeu a um pedido de reavaliação feito pela Farsul e lideranças políticas, após a exclusão inicial de 92 municípios gaúchos.
Com a revisão, todos os produtores do Vale do Taquari passam a ter acesso à linha de crédito criada para agricultores afetados por perdas climáticas, viabilizada por meio do repasse de R$ 12 bilhões do governo federal ao Banco Nacional de Desenvolvimento Econômico e Social (BNDES), oficializado na quarta-feira, 15. O recurso permitirá a liquidação ou amortização de dívidas de custeio, investimento
e Cédulas de Produto Rural (CPRs), com juros entre 6% e 10% ao ano. No Estado, 56 municípios foram incluídos na atualização. Agora 459 estão aptos a participar do programa, que contempla cerca de 100 mil produtores em todo o país.
Levantamento
Segundo levantamento da Farsul, as quatro cidades agora incluídas acumulam R$ 290 milhões em dívidas rurais — reflexo dos prejuízos causados por eventos climáticos recorrentes entre 2020 e 2025.
A entidade havia contestado os critérios técnicos adotados pelo Mapa, que consideravam apenas as três culturas com maior área plantada, e sugeriu que fossem levadas em conta as atividades de maior valor econômico.
Com a reavaliação, os produtores locais passam a ter direito à renegociação de débitos e à possibilidade de retomar investimentos nas propriedades, amenizando os impactos da estiagem e das enchentes que atingiram o Estado nos últimos anos.


UMAS & OUTRAS
CARLOS MARTINI Administrador
TÁ CHEGANDO A HORA
Em breve todas as obras de melhorias mais próximas na BR-386 estarão concluídas, com um certo atraso, mas rigorosamente de acordo com o previsto no contrato de concessão e muito bem saudadas à época.
Na “subida da serra”, trechinho bem complicado, a coisa vai um pouco mais longe, mas segue evoluindo.
Já surgiram diversas reivindicações complementares por novas melhorias, de maior ou menor envergadura, inclusive em função de recentes ocorrências climáticas, mas também por algumas “sintonias finas” que podem ser aprimoradas nas conexões então projetadas com as malhas de arruamento e de trânsito locais.
Natural que ocorram e todas são legítimas, questão de ajustar os diálogos técnicos e negociações para eventuais ajustes para a necessária viabilização econômico-financeira de obras de maior envergadura.
Para isso não faltarão bons interlocutores com maiores e melhores conhecimentos, de todas as partes interessadas, como não faltou por ocasião da própria implantação da rodovia em tempos idos, da posterior duplicação em seu principal eixo local de travessia do Taquari
e suas várzeas, nos providenciais alargamentos de pista de “Tabaí para baixo” e de “Marques para cima”, no belo trecho já duplicado entre Estrela/Tabaí, sem contar várias outras melhorias de menor envergadura.
Não custa lembrar quantos sufocos passados já foram resolvidos ao longo do tempo e valorizar adequadamente o que agora vem sendo concluído e entregue, que não é pouco.
Talvez passe em brancas nuvens, mas na minha humilde avaliação até merecia um “foguetório” das antigas.
VIA SATÉLITE!
Não há como negar que a organização de consórcios legalmente constituídos foi uma baita mão na roda e continua sendo nos negócios sérios em geral, inicialmente pra venda de imóveis e também se espraiando por confiáveis revendas de caminhões e automóveis, aí até contando com inovadores leilões “presenciais”, via satélite! Hoje em dia existem canais tecnológicos bem mais avançados para esses mesmos fins e objetivos, mas dava gosto de ver a agilidade, a confiabilidade e o jogo de ganha-ganha dos parceiros interagentes. Consórcios em setores públicos,
PRÓXIMA PARADA
Dizem os astrônomos que a constelação de estrelas mais próxima do planeta Terra, na galáxia Via Láctea, é a de Andrômeda. Segundo o meu Cumpádi Belarmino, a tal Via Láctea fica até bem próxima da Bossoróca, coisa de uma mera dúzia e meia de milhões de anos-luz de distância, se tanto. Com os atuais avanços tecnológicos e jurídicos em licitações públicas, inclusive via pregões eletrônicos, surgem propostas de tudo quanto é lado, até das imediações da Constelação de Andrômeda.
Consistentes ou não, cabe
avaliar cada uma com os devidos critérios jurídico-administrativos. Amplia a sempre saudável concorrência, afeta interesses consolidados internos, é coisa séria ou mera picaretagem de ocasião, comprovada a necessária idoneidade tem capacidade de aguentar o rojão abaixo de eventuais chuvas e trovoadas, sem fugir da raia?
No setor privado não é lá muito diferente, embora as decisões administrativas não dependam de tantas “burrocraciais” e regrinhas jurídicas institucionalizadas.
Confiabilidade é a palavra-chave, sempre essencial.
inclusive intermunicipais, vieram mais tarde um pouco, meio que a reboque da chamada iniciativa privada, para não variar muito.
Também foram considerados como uma potencial e importante mão nas respectivas rodas administrativas, sobretudo para pequenos municípios e em diferentes setores. Alguns avançaram mais, outros talvez tenham meio que ficados parados no tempo.
Boa hora prá repensar, afinal vários já procuraram outros caminhos pra trilhar.
PROPOSTA INTERESSANTE
Segundo as notícias, pelo jeito pode se criar um interessante centro logístico alí pela boa terra de Marques de Souza. E eu torço para que se crie e apareça.
A navegação de longo curso também passa por aí e uma pousada segura é sempre bem-vinda.
Historicamente talvez nem seja uma novidade nesse ponto geográfico de descida/subida da serra, afinal essas imediações já foram consideradas como pontos nevrálgicos comerciais, de logística e até militares em tempos idos.
Agora talvez até revigorados.
SAIDEIRA
Neto pro nôno, duas horas na beira do rio dando ¨banho nas minhocas¨ e sem nenhuma fisgada:
- Vô, qual a melhor hora pra pescar?
- Meio-dia e cinqüenta e nove minutos!
- Nossa! De onde o senhor tem todo esse conhecimento cronométrico?
- Paciência e sabedoria de pescador: ¨UMA HORA vai ter que dar peixe nessa (*)ôrra!¨ ...agora só falta mais um minuto.
ARTIGO

MARCOS FRANK
Médico
Neurocirurgião
O longo caminho da medicina
Embora eu seja professor universitário há 23 anos, foi somente há 11 anos que pude me dedicar a auxiliar na formação de jovens médicos.
Quando esses aspirantes a médico chegam a universidade, eles compreensivelmente se identificam muito mais com os pacientes do que com seus futuros pares. Aproveito essa ocasião para perguntar-lhes como são vistos os médicos de suas cidades e invariavelmente muitos listam qualidades negativas como insensíveis, rudes e mercenarios.
A próxima pergunta que faço, logo após a primeira é: o que vocês vieram fazer então, numa escola médica que ajuda a formar tão torpes profissionais? Ao que eles respondem: nós seremos diferentes!
Louvável intenção , mas o que ensinar a esse jovens para que aumentem a capacidade de praticar a medicina, melhorar a experiência do pacientes e, ao mesmo tempo,transforma-los em grandes médicos?
Me atrevo a listar dez objetivos:
1. Torna-los um mestre na escuta, praticando a escuta ativa e focando atenção tanto no que está sendo dito como também na linguagem não verbal.
2. Escutar bem exige boa saúde tanto física quanto mental, pois é impossível pratica-la estando exausto ou irritado. Eles terão de aprender que para cuidar dos outros, também precisarao cuidar de si mesmos.
3. O grande médico inglês Sir William Osler já advertia: “Um bom médico trata a doença. O grande médico trata o paciente que tem a doença”. É fundamental aprender a tratar o paciente como um todo.
4. Encontre sua paixão. A medicina é tão ampla e tão variada que permite a todos que a praticam encontrar sua verdadeira vocação.
5. Ensinar a ter a mentalidade de um detetive e ir mais a fundo quando algo não estiver dando certo no tratamento de um paciente. Um bom médico deve perceber quando pegou um caminho errado.
6. Praticar empatia através dessas três frases e se colocando no lugar do paciente: 1) “O que você pensaria?” 2) “Como você se sentiria?” e 3) “O que você gostaria que alguém fizesse por você?”
7. Não são os mais fortes de uma espécie que sobrevivem, nem os mais inteligentes, mas os mais resilientes e responsivos às mudanças. A resiliência é necessária para sobreviver à exposição frequente à doença e à morte que os médicos enfrentam.
8. Aprender a assumir responsabilidades, sem fugir delas nos momentos mais críticos e mais difíceis. Os grandes médicos não abandonam seus pacientes.
9. E preciso aprender a agradecer pelo que conquistou. Quando você realmente segue suas pai xões, o dinheiro e a fama serão um subproduto de seus esforços. Além disso a gratidão em relação às vidas que você melhorou e salvou são um potente estímulo para seguir em frente.
10. Esteja sempre atento: 1) Atenção aos detalhes; 2) Sempre tenha um plano B caso ocorra um problema; 3) Tudo o que fazemos ou dizemos, ou deixamos de fazer ou dizer, tem consequências; e 4) Nem todos os pacientes se comportam ou respondem da mesma forma. Um feliz dia dos médicos a todos que honram nossa profissão. Inspirado em : Dez características de grandes médicos . Higgins JP. Am J Med. 2023 abr;136(4):355-359.


365 VEZES NO VALE

365vezesnovaledotaquari@gmail.com
Patrocínio

Jardim de Arvorezinha oferece novo conceito gastronômico no Vale
Nos ervais de Arvorezinha surge uma experiência culinária requintada e focada na verdadeira cozinha italiana. O Giardino di Famiglia inaugurou há dois meses com a proposta de ser um jardim familiar e oferecer uma verdadeira viagem gastronômica aos visitantes.
O empreendimento nasce da união do chef carioca Alex Szigethy e da empresária arvorezinhense Gissele Zillmer.
Com 20 anos de atuação, Szigethy tem experiência internacional.
Em Caxias do Sul, os restaurantes administrados por ele são reconhecidos por premiações.
Em um deles, o Le Coq Bistrô, ele conheceu Gissele.
Após o matrimônio, o casal resolveu transformar a chácara da família Zillmer num restaurante. O terreno com gramado verde preserva a natureza e ao mesmo tempo está bem localizado, ao lado do pórtico de Arvorezinha, na rua Angelo Dall’Agnol.
Da estrada, o prédio envidraçado e com deck enorme chama atenção de quem passa.
O cardápio conta com mais de 40 tipos de pratos, muitos deles, encontrados regionalmente apenas no Giardino di Famiglia.
A proposta da casa é focar na culinária encontrada atualmente nos restaurantes da Itália.
A cozinha com alma explora as massas, pizzas e risotos. Tem opções singulares como o Filé a Wellington (filé envolto em lâminas de Presunto de Parma e coberto por massa folhada assada) e o Nhoque de batatas com

iscas de filé.
Outro diferencial é a adega interativa no qual o cliente pode entrar e escolher o próprio vinho ou espumante, além de uma série de drinks estilizados, chope e bebidas em geral.
Jardim de família
O nome Giardino di Famiglia vem do italiano e significa “jardim de família”. Essa é justamente a proposta do restaurante. Além da experiência gastronômica, oferecer ao visitante um espaço para passar momentos relaxantes e memoráveis.



O atendimento ocorre de quartas a sábados à noite e fins de semana ao meio-dia com menu à la carte italiano e de pizzas napoletanas. Em momentos especiais, também serve sequências de massas e risotos. O espaço também pode ser locado para eventos particulares.
Mais informações podem ser encontradas no perfil @giardinodifamiglia no Instagram. O contato de WhatsApp é o 51 98035-4626.





Localização: Rua Angelo
Dall’Agnol, 1.175, centro de Arvorezinha
Atendimento:
Quartas a sábados das 19h às 22h30min Ao meio-dia nos sábados e domingos
Contato: @giardinodifamiglia 51 98035-4626
REFLORESTAMENTO
Município planta 45 árvores na Bento Rosa
Enchente de maio de 2024 arrancou vegetação que existia no trecho. Local virou ponto de contemplação do rio. São 21 Guapuruvus e 24 Flamboyants
LAJEADO
Ogoverno de Lajeado iniciou nessa quintafeira, 16, o plantio de 45 árvores às margens do Rio Taquari, na rua Bento Rosa, no Bairro Carneiros. A ação é executada pela Secretaria de Serviços Urbanos (Sesu) e integra o Programa Lajeado Mais Verde. Das 45 mudas, 21 delas são Guapuruvus e 24 são Flamboyants.
“São árvores de floração abundante nos meses de verão e que oferecerão bastante sombra e beleza neste local que começa a ser frequentado pela comunidade,” – destaca a coordenadora da secretaria, Anelise Bohn. Ela explica que o Guapuruvu é uma espécie de grande porte e que tem um crescimento rápido e o Flamboyant já é uma espécie de médio porte.
O trabalho consistiu na abertura de valas grandes com uso de
mini-escavadeira e preenchimento com terra, para possibilitar o desenvolvimento das árvores, uma vez que o local do plantio foi recomposto com pedras devido ao desbarrancamento ocasionado pelas enchentes. Também está sendo feito o estaqueamento e amarração das mudas, para protegê-las da ação do vento e facilitar a pega.
Conforme Anelise, há duas semanas foram plantadas 4 mudas de butiazeiros e 14 da espécie Pau-ferro, na rua Carlos Spohr Filho, no bairro São Bento.
Lajeado Mais Verde
O Programa Lajeado Mais Verde foi lançado pela Prefeitura de Lajeado no dia 21 de setembro (Dia da Árvore) de 2017 com o plantio de mudas na Avenida Senador Alberto Pasqualini. O

Programa foi lançado em 2017 e consiste em implementar a arborização urbana responsável
objetivo do programa é implementar a arborização urbana responsável do Município de Lajeado através da realização de plantios em áreas escolhidas pela
Comissão Municipal da Arborização Urbana e em locais elencados pela comunidade. Até o momento, foram plantadas 3.931 árvores por meio do programa. Somente
em 2025, ocorreu o plantio de 250 mudas. Contudo, ainda não foram contabilizadas no programa as árvores plantadas pela Sesu este ano.

Obra coletiva com 30 autores terá direitos revertidos à Slan
Em parceria com o Tittanium Club, a autora Fernanda Tochetto e o marido Isaac Bertuol incentivam generosidade
LAJEADO
Aautora Fernanda Tochetto destaca o lançamento de uma obra coletiva que vai reverter em benefícios para a Slan. Ela e o marido Isaac Bertuol, são os organizadores da obra Construa Negócios com Identidade.
Mais de 30 autores espalhados pelo país estão no projeto que ensina estratégia para ecossistemas de alto valor e resultado sólido. E na verdade, uma nova visão de empreendedorismo, mais moderno e com significado.
Todos os direitos autorais da obra serão destinados à Slan, instituição que acolhe crianças e adolescentes em Lajeado. “De 10 de outubro a 10 de novembro, todo o valor arrecadado com as vendas será revertido à entidade”, conta Fernanda. Além disso, ela prepara uma palestra para o time da Slan, com o propósito de fortalecer quem cuida, quem educa e quem sustenta o afeto ali dentro.
Sobre a escolha da Slan, Fernanda fala com emoção. “Desde que vim morar em Lajeado, essa
é uma instituição que me toca. Eu visito, conheço o trabalho e tenho um carinho muito especial. A questão das crianças que não têm pai ou mãe mexe comigo de um jeito profundo. Sempre que posso, faço algo por elas.”
Na próxima semana, Fernanda fará uma palestra para os professores e colaboradores da Slan e pretende manter o vínculo com novas ações. “Quero continuar contribuindo e inspirando outras pessoas a fazer o mesmo. Esse movimento de doar, de colocar o amor em prática, é o que dá sentido a tudo.”
Obra coletiva
A obra Construa Negócios com Identidade reúne profissionais de

Valores de direitos autorais da obra serão destinados à Slan, instituição que acolhe crianças e adolescentes em Lajeado
várias áreas e regiões do Brasil que abrem suas trajetórias para mostrar o que há por trás dos resultados: as tentativas, os acertos, os recomeços.
São 224 páginas de histórias, ferramentas e aprendizados que cruzam a técnica com a vida real, um convite a empreender de um jeito mais humano, consciente e sustentável.
Psicóloga, empresária, mentora, escritora best-seller e
podcaster, Fernanda Tochetto já soma seis livros publicados, entre eles o Destrave a Sua Vida e Saia do Rascunho, cujos direitos autorais foram doados à Associação dos Deficientes Auditivos de Lajeado.
Isaac Bertuol é neurocirurgião desde 2006 e cofundador do Tittanium Club. Organizador, junto com a esposa Fernanda, da obra Construa Negócios com Identidade.

www.coquetel.com.br
CRUZADAS
Cautelosa; prudente Tímpano (Anat.) (?) Moscovis, ator carioca
Mãe de Draco Malfoy, nos livros de "Harry Potter" Pálido, em
Diz-se das orações unidas por conjunção aditiva (Gram.)
Harmoniza; concilia Guiomar Novais, pianista brasileira Ampère (símbolo)
Cruel; perversa 500, em romanos 3/aim — doo — icá. 4/apar — erês — pale. 7/narcisa. 10/sindéticas. 16/ruínas de chanchan.
Trombeta indígena Descerrei
Portão xintoísta "(?) Neon", filme do cineasta Gabriel Mascaro (2015)
Foi infiel Diálogo de Platão

Observa Variante

ÁRIES: Organize o dia por prioridades, por exemplo, duas entregas e uma conversa decisiva. Ajuste a rotina com blocos de atividades e pausas.
TOURO: Conversas de hoje trarão soluções originais e mais espaço para o prazer. Se estiver só, poderá se apaixonar
GÊMEOS: Conversas leves poderão resultar em novos projetos a dois, evite maratonas de discussão e solte a criatividade.
CÂNCER: Organize a casa, deixe contas e compras em ordem e combine regras simples em família. No amor, presença e escuta diminuirão ruídos.
LEÃO: Circule, amplie amizades, aproxime irmãos e some forças com a família em novos projetos
VIRGEM: Padronize processos, implante novas ferramentas, faça pequenos reparos e elimine a pendência que estava travando seu movimento.

LIBRA: Renove os looks, a imagem e comece um novo ciclo em sua vida. Música, arte, conexão com a natureza e viagem alimentarão a alma.
ESCORPIÃO: Conquistas pessoais importantes e decisões de vida. Finalize um ciclo e parta para ação!
SAGITÁRIO: Um toque de estética nos materiais e apresentações aumentará a adesão.
CAPRICÓRNIO: Você poderá se associar num empreendimento ou firmar uma proposta bem remunerada e subir um patamar na carreira.
AQUÁRIO: Aproveite para definir novas metas profissionais, sua elegância e leveza serão ferramentas estratégicas para firmar a reputação.
PEIXES: Dê forma prática às boas intenções. Ajuste a rotina, organize contas básicas e crie um minirritual para manter a concentração.



REGIONAL ASLIVATA
CONFRONTOS ENTRE CAMPEÕES MARCAM AS OITAVAS DE FINAL

Em Conventos, Estudiantes e Brasil fazem duelo de quatro taças de campeão da categoria titular
Partidas de ida da Série A ocorrem em seis cidades do Vale do Taquari e duas da Serra
Ezequiel Neitzke ezequiel@grupoahora.net.br
Após oito rodadas, o Regional Aslivata entra em uma nova fase a partir deste domingo na Série
A. Os jogos de ida das oitavas de final ocorrem em seis cidades do Vale do Taquari e duas da Serra. O aspirante inicia às 14h enquanto os titulares começam às 16h. O destaque da rodada fica por conta dos confrontos entre campeões. Em Conventos são quatro títulos em campo. O Estudiantes, detentor da taça de 2023, recebe o Brasil, tricampeão na década de 90. As duas equipes já se enfrentaram na temporada e em um jogo frenético, o Brasil venceu por 3 a 2. Outro duelo entre campeões ocorre em Guaporé. Atual campeão, o Juventude recebe o Canabarrense, de Teutônia.
REENCONTROS
Além do duelo em Conventos, as oitavas de final colocam frente a frente outros dois confrontos que ocorreram na classificatória. O Imigrante retornou ao Regional Aslivata nesta temporada. O time de Nova Bréscia enfrenta
AGENDA
SÉRIE A – OITAVAS DE FINAL/
JOGO DE IDA
LAJEADO – Estudiantes x Brasil
IMIGRANTE – Ecas (CAN) x Minuano
TEUTÔNIA – Gaúcho (Sete de Setembro) x Nacional
BOM RETIRO DO SUL – Rudibar x Poço das Antas
NOVA BRÉSCIA – Imigrante x Taquariense
GUAPORÉ – Juventude x Canabarrense
BOA VISTA DO SUL – Boavistense x Serrano
WESTFÁLIA – Juventude x Tiradentes
CATEGORIA ASPIRANTE VETERANO – ÚLTIMA RODADA
SANTA CRUZ DO SUL – Flamengo x Floriano
o Taquariense. Os clubes se enfrentaram em 31 de agosto e o Taquariense venceu por 3 a 2. Outras equipes que se reencontram é Poço das Antas e Rudibar. Em 17 de agosto, em jogo disputado em Poço das Antas, empataram em 3 a 3.
ASPIRANTE
A rodada colocará frente a frente clubes que terminaram com campanhas parecidas. Os destaques ficam para o duelo entre Estudiantes x Brasil e Juventude Westfália x Tiradentes.
VENÂNCIO AIRES – São Luiz x Penharol
VENÂNCIO AIRES – Assespe x Sete de Setembro
ROCA SALES – Concórdia x Rudibar
CLASSIFICAÇÃO: Concórdia (11 pontos), São Luiz e Floriano (9), Rudibar (8), Serrano (7), Penharol (6), Sete de Setembro (5), Flamengo (4) e Assespe (1);
SÉRIE B
CANUDOS DO VALE – Nova Berlim x 11 Amigos
LAJEADO – Guarani x Delfinese
TITULAR: 11 Amigos, Nova Berlim e CMD (9 pontos), Delfinense (8) e Guarani (3);
ASPIRANTE: CMD (17 pontos), Nova Berlim e 11 Amigos, Delfinense (4) e Guarani (3);
VETERANO
A última rodada da fase classificatória ocorre neste domingo. Sete clubes já estão classificados para as quartas de final. O Flamengo, de Santa Cruz do Sul, se classifica até com derrota, desde que não seja advertido com cinco cartões. Ou seja, para avançar de fase, a Assespe tem que vencer e torcer para que o Flamengo sofra as punições no confronto contra o Floriano. A rodada também tem a disputa pela liderança. Concórdia (11 pontos), São Luiz e Floriano, ambos com nove, brigam pela vantagem nos mata-mata.

ZONA DESCONFORTÁVEL
SEM CHANCE PARA ERRO CONTRA O LANTERNA
Má atuação e proximidade da zona de rebaixamento acendem alerta no Internacional diante do virtual rebaixado Sport
Caetano Pretto caetano@jornalahora.net.br
Com urgência de vitória, o Internacional joga neste domingo, 19, às 18h30min, contra o lanterna Sport, no Beira-Rio. O alerta está ligado com a proximidade da zona de rebaixamento após derrota e má atuação contra o Mirassol. O clube convoca a torcida, e dentro de campo, Ramón Díaz tem novas possibilidades para a escalação. A Rádio A Hora transmite o confronto.
A expectativa era de melhora após mais de dez dias para treinar na Data Fifa. O jogo passado, no entanto, foi preocupando. O Inter perdeu de 3 a 1 e viu a diferença para a zona de rebaixamento diminuiu com o êxito do Vitória no clássico Ba-Vi. 15º, com 32 pontos, o clube gaúcho tem apenas quatro pontos de vantagem para o 17º.
A notícia positiva para o fim de semana é que o adversário é o virtual rebaixado Sport, lanterna com apenas 17 pontos e só duas vitórias no campeonato.
NOVIDADES NO TIME TITULAR
Ramón Díaz deve promover alterações na equipe titular. Se optar pelo esquema com três zagueiros, Juninho deve entrar no lugar de Victor Gabriel. No meio-campo, Alan Rodríguez deve atuar no lugar de Bruno Henrique. E no ataque, Carbonero retoma a titularidade na vaga de Romero. A principal dúvida recai sobre Anthoni. Após falhar em todos os gols do Mirassol, o goleiro pode perder o lugar no time para Ivan. O terceiro goleiro colorado não atua desde janeiro de 2024.
O time titular deve ter: Anthoni (Ivan); Vitão, Mercado e Juninho; Aguirre, Thiago Maia, Alan Rodríguez e Bernabei; Alan Patrick, Carbonero e Vitinho.
SPORT VIRTUAL REBAIXADO
Apenas um milagre salva a temporada do Sport. Virtualmente rebaixado, a diferença para o Santos, primeiro time fora da zona do rebaixamento, é de 14 pontos. O time titular para domingo deve ter: Gabriel; Aderlan, Rafael Thyere, João Silva e Luan Cândido; Zé Lucas, Pedro Augusto, Lucas Lima e Matheusinho; Romarinho e Derik Lacerda.
CLASSIFICAÇÃO

AGENDA
29ª RODADA - SÁBADO
16h
18h30min
18h30min
18h30min
20h30min
DOMINGO SEGUNDA-FEIRA

Ausência
EM SALVADOR
GRÊMIO BUSCA SEQUÊNCIA POSITIVA PARA CONTINUAR SONHANDO
A vitória e boa atuação contra o São Paulo trazem otimismo ao Grêmio. Sem tempo para descansar, o Tricolor já viaja para Salvador e neste domingo, 19, às 20h30min, encara o Bahia na Arena Fonte Nova. A Rádio A Hora transmite o confronto.
Os dois gols de Carlos Vinícius levaram o Grêmio aos 36 pontos, na 11ª colocação. No meio da tabela, os próximos jogos dirão qual será a briga até o fim do campeonato. São sete pontos de distância para o sexto colocado, o último na zona de classificação à Libertadores, o próprio Bahia. Portanto, vitória na rodada significa manutenção da esperança por um fim de ano positivo.
Para o confronto, Mano Menezes terá o retorno de Marlon e Kannemann, suspensos na partida passada. O lateral deve voltar ao time titular, enquanto que o zagueiro argentino
disputa posição com Wagner Leonardo. Com a suspensão de Dodi, Cuéllar volta ao seu lugar ao lado de Arthur.
O provável Grêmio tem: Gabriel Grando; Marcos Rocha, Noriega, Kannemann (Wagner Leonardo) e Marlon; Cuéllar, Arthur e Edenílson; Pavón, Amuzu e Carlos Vinícius.
DERROTA NO BA-VI
O time baiano perdeu o clássico Ba-Vi para o Vitória e desperdiçou a chance de encostar no G4 do Brasileirão. Com 43 pontos, tem seis a menos do que o Mirassol, quarto colocado. O time titular deve ter: Ronaldo; Santi Arias, David Duarte, Gabriel Xavier e Iago Borduchi; Acevedo, Jean Lucas e Rodrigo Nestor (Cauly); Ademir, Sanabria e Tiago.
DIVISOR DE ÁGUAS
FINAL PARA COROAR UMA GERAÇÃO
Comandados por um técnico do Vale do Taquari, garotos do Grêmio entram em campo para confirmar vantagem e levar o título do Brasileirão Sub-17
Antes mesmo de alçar voos no futebol profissional, uma geração de garotos do Grêmio pode fazer história neste sábado. Em vantagem após golear na partida de ida, o Tricolor pode perder por até dois gols de diferença para sagrar-se campeão do Brasileirão Sub-17. A partida contra o Atlético-MG ocorre neste sábado, às 11h, na Arena MRV.
O sucesso do Grêmio no campeonato tem uma forte ligação com o Vale do Taquari. Comandante da equipe, Ruimar Kunzel é natural de Marques de Souza. São mais de dez anos de serviço ao clube até chegar ao momento que pode ser transformador na sua carreira.
Para chegar na final, o Grêmio eliminou em jogo único dois

fortes adversários e que tinham campanhas superiores. Primeiro tirou o Bragantino, quarto colocado, nas quartas de final. Depois passou pelo Palmeiras, dono de melhor campanha e considerado o favorito, na semifinal.
Na ida da decisão, na Arena, venceu por 4 a 1 o Galo em uma grande atuação. “Fizemos um grande primeiro jogo e temos boa vantagem. Em finais tudo é equi-

librado, mas esperamos coroar o trabalho com o título que será de extrema importância para os garotos, para mim como profissional, para a base do Grêmio e para o clube de uma forma geral. Vamos até o fim para conquistar o objetivo e levantar esta taça” destacou Kunzel.
TAÇA PODE VIR ATÉ COM DERROTA
Na ida, o Tricolor venceu por 4 a 1, com gols de Lucca, duas vezes, João Borne e Roger. Na volta, o Grêmio pode perder por até dois gols de diferença que conquista o título da competição. O provável time titular tem: Gabriel Menegon; Vitor Ramon, David Brendo, Luiz Eduardo e Lucas Rian; Danillo, Tiago e João Borne; Roger, Gabriel Mec e Lucca.
Grêmio é comandado por Ruimar Kunzel, técnico natural de Marques de

Equipe de Venâncio Aires venceu todas as partidas até agora na Terceira Divisão do Gauchão
DE TÉCNICO NOVO, GUARANI BUSCA MANTER 100%
Ezequiel Neitzke ezequiel@grupoahora.net.br
Com três vitórias em três jogos, o Guarani, de Venâncio Aires, volta a campo neste domingo. A partir das 15h, encara o Nova Prata, em Nova Prata, em jogo válido pela quarta rodada da Terceira divisão.
O confronto marca a estreia oficial do técnico Eder Lazzari.
Antes assistente de Gilmar Iser, foi efetivado ao longo dessa semana. Inclusive, Lazzari dirigiu o time na última rodada, quando venceu o Clube 1992, em Venâncio Aires.
Segundo o diretor de futebol Dudu Kuhn, a promoção de Eder é resultado de um processo natural dentro do clube. “Ele segue o andamento natural, ele seria, mais cedo ou mais tarde, o treinador da equipe principal.
Deu-se essa oportunidade agora e ele está agarrando com as duas mãos”, destacou o dirigente.
Como atleta, Eder Lazzari foi
revelado pelo próprio Guarani no fim da década de 1990 e defendeu o clube por sete temporadas, conforme informações do site Ogol.
Para o final de semana, o Guarani só não conta com o lateral-esquerdo Johnny ainda se recuperando da lesão na coxa. O restante da equipe deve ser a mesma que venceu o Clube 1992 – Maicon, Cairu, Turatti, Dieter, Sampson, Gabryel, Mateus, Murilo, Vitor, Pablo e Lucão.
OUTROS JOGOS
No outro jogo do grupo, o Clube 1992 recebe em Carazinho, o Novo Horizonte.
A classificação tem Guarani líder com 9 pontos. Ele é seguido de Apafut com 4, Nova Prata, Clube 1992 e Novo Horizonte, todos com 1.
Após o jogo deste domingo, o Guarani terá duas semanas de folga e retorna a campo apenas em 2 de novembro.

por Raica Franz Weiss





Construmóbil 2005 movimentava Lajeado

A feira de construção civil, mobiliário e decoração do Vale do Taquari, a Construmóbil 2005, chegava à segunda edição. O evento ocorria no Parque do
Imigrante em Lajeado, com o slogan “Você faz. O Vale mostra”. A expectativa era superar os R$ 10 milhões em negócios da última edição, em 2003, e reunir em tor-
no de 150 mil visitantes.
A Construmóbil era organizada pela Associação Comercial e Industrial de Lajeado (Acil) e tinha mais de 250 estandes vendidos. A comissão organizadora era presidida pelo arquiteto Giancarlo Bervian.
A Construmóbil foi idealizada para dar destaque ao setor da construção civil. Os jornais da época noticiaram que, em 2004, cerca de 200 mil metros quadrados de área foram aprovados para a construção. De janeiro a agosto de 2005, em Lajeado, mais de 700 novos projetos de imóveis foram aprovados em Lajedo.
Debut de Lajeado
O Clube Tiro e Caça de Lajeado organiza mais uma noite de gala na cidade, o Baile de Debutantes de 1975. Ao todo, 37 moças foram apresentadas à sociedade naquela noite. Naquele ano, o tema da decoração foi a Era Medieval. Depois do baile, acontecia ainda o Chá Destaque das Debutantes, promovido pelo Rotary Club de Lajeado, junto com o desfile de primavera/verão da Casa Americana. As debutantes também desfilaram mais uma vez no Baile da Brotinho, que escolhia a jovem representante de Lajeado para 1975 na categoria. A lista com o nome das debutantes de 1975 não foi encontrada nos jornais da época.

Enquanto isso…


Beatles eram ícone do século XX - A banda britânica liderava o ranking dos cem principais ícones do cenário artístico do século XX, feito pela revista Variety em 2005. Os quesitos avaliados incluíam impacto comercial e criativo dos artistas, número de imitadores e o uso da imagem em produtos como camisetas. A lista apresentou diversos nomes de ícones do cenário artístico do século XX, cantores, atores, diretores e até personagens como Mickey Mouse. Conforme a Variety, os dez ícones eram The Beatles (1º), Louis Armstrong (2º), Lucille Ball (3º), Humphrey Bogart (4º), Marlon Brando (5º), Charlie Chaplin (6º), James Dean (7º), Marilyn Monroe (8º), Mickey Mouse (9º) e Elvis Presley (10º).


Sábado é Domingo é
- Dia do Médico
- Dia do Pintor
- Dia do Estivador
- Dia Nacional de Combate à Sífilis
- Dia Mundial da Menopausa
Santo do dia: São Lucas
- Dia Mundial das Missões
- Dia do Profissional de Informática
- Dia do Guarda Noturno
- Dia Nacional da Inovação
- Dia do Operador de Caixa
- Dia do Profissional de Tecnologia da Informação
- Dia do Piauí
- Dia Internacional de Combate ao Câncer de Mama
Santo do dia: São Pedro de Alcântara



HENRIQUE PEDERSINI
Jornalista
Afinal, “quem é” a PDS?
Omote da CPI instaurada na câmara de Lajeado são, até agora, 85 serviços prestados (ou não) pela PDS Obras Ltda. O grupo de vereadores encaminhou um cronograma para revisão de todos os locais onde podem ter ocorrido desde erros na execução até fraude e prepara a contratação de uma perícia para produção de relatório técnico. Após o entrave na definição dos cargos dentro da comissão e a superação dos embates políticos, São 15 dias de CPI e os vereadores, parte do governo, imprensa e principalmente a sociedade não sabem quem são os rostos, vozes e CPF’s oculto pela inscrição jurídica da PDS Obras Ltda. A identificação é fundamental, pois permite entender o processo de escolha deste específico CNPJ. Aliás, o vereador Éder Spohr (MDB) assegura que se trata dos mesmos nomes investigados há mais de 10 anos em Lajeado. A maneira como a empresa apresentou uma defesa informal aos vereadores é esquisita. Um pendrive entregue para um assessor do vereador Ramatis de Oliveira (PL) ao final da sessão ordinária da última terça-feira não é o modo adequado de manifestar-se pela primeira vez

sobre o assunto que envolve uma sindicância do município, uma CPI, o Ministério Público e causou ainda a saída de um secretário municipal além o procurador jurídico da câmara. Aliás, por mais que tenha sido incluída nos documentos da CPI, os arquivos não satisfazem os vereadores como garantia de eficiência e, acima de tudo, legalidade do processo milionário.
A empresa que recebeu pelos serviços será acionada para prestar esclarecimentos e isso será em breve uma vez que o processo
todo tem prazo de, no máximo, 60 dias. A mesma pergunta que intitula a coluna foi repetida a vários dos integrantes da câmara e não há certeza sobre a identidade dos responsáveis. Há quem afirme, publicamente, que há intermediários, os chamados “laranjas” colocados para proteger o real mandatário da PDS.
É missão da CPI, da sindicância feita pelo município apurar de quem é a empresa de fato e confirmar se os serviços prestados estão de acordo com os pagamentos feitos.
O Vale, enchente e a COP 30


ARTIGO

ROGÉRIO WINK
Empreendedor e comunicador, apresentador do programa “O Meu Negócio”, da Rádio A Hora 102.9
Acompanho muitos profissionais que estão sempre online. Estão em todas as conversas, respondem no mesmo minuto, entram em reuniões de última hora, não deixam nenhuma notificação passar. Isso parece produtividade, mas na prática é o contrário. A falta de critério transforma esse excesso de conexão em “trabalho sobre o trabalho”. Muito esforço para alinhar, pouco tempo para executar.
O dia vira uma sequência de interrupções disfarçadas de urgência. O cérebro pula de um tema para outro, sem espaço para aprofundar. O resultado é previsível: dispersão, cansaço, sensação de que nunca dá para zerar a fila. Para piorar, a agenda cheia de reuniões dá a falsa impressão de que se trabalhou muito, quando na verdade pouco avançou. É um caminho rápido para a exaustão.
Tem boa notícia: não é preciso se desconectar para recuperar foco. É preciso organizar. Quando existem regras claras e disciplina, a hiperconectividade deixa de ser ruído e vira alavanca de execução.
Observo pontos relevantes que geram soluções. Sobre notificações, o que não ajusta como prioritário, desliga. Deixa apenas para menções relevantes e define janelas para checar mensagens durante o dia. Fora disso, ativa o “não incomodar”. Se for urgente, que liguem. Essa regra básica já reduz mais da metade das distrações.
A 30ª edição da Conferência das Partes da Convenção-Quadro das Nações Unidas sobre Mudança do Clima, a COP 30, ocorrerá em Belém de 10 a 21 de novembro e, como várias situações neste mundo, tem um recorte do Vale. Nesta edição do evento, serão dois. O diretor-executivo do Pro_ Move Lajeado, Thiago Guerra, estará em Belém (PA) e, ao que tudo indica, apresentará no palco o case sobre a eficácia de resposta à catástrofe climática a partir da quádrupla hélice. O projeto foi inscrito e tem grandes chances de virar pauta um dos momentos da programação.
O deputado estadual Professor Bonatto (PSDB) levará a Belém dois projetos sobre adaptação climática e da sustentabilidade. Um deles estabelece o Plano Estadual de Recuperação Ambiental do Vale do Taquari. São ações de reflorestamento com espécies nativas, recuperação de nascentes e matas ciliares, e incentivo a práticas de irrigação sustentável.
Tem boa notícia: não é preciso se desconectar para recuperar foco. É preciso organizar”
Reuniões também precisam de limite. Estudos de produtividade apontam que executivos passam boa parte do tempo em reuniões — e muitos reconhecem que uma parcela significativa delas não gera resultados concretos. Antes de marcar, vale avaliar três “Ps”: Propósito (qual decisão precisa ser tomada?), Produto (qual o resultado desejado?) e Prazo (quanto tempo é suficiente?). Se não houver clareza, não há motivo para reunião. Em muitos casos, um simples e-mail resolve melhor e substitui encontros desnecessários.
Outro ponto é a disponibilidade. O papel da liderança é decisivo. Conheço líder que responde mensagens a toda hora, participa de todas as conversas, entra em reuniões sem filtro e até dispara recados na madrugada. Esse comportamento, mesmo sem intenção, treina o time pelo exemplo e instala a cultura da urgência permanente. É como se o “sempre online” fosse a régua de comprometimento.
Na prática, o efeito é o oposto. Equipes passam a trabalhar no modo reativo, sem espaço para análise e execução. Tudo vira prioridade, ninguém consegue diferenciar o que é estratégico do que é barulho.
Estar online não é sinônimo de estar produtivo. O “sempre online” só funciona quando está a serviço do que realmente importa. Mas reconhecer o problema não basta: é preciso agir. O excesso de conexão seduz e cria a falsa sensação de controle e urgência. Transformar isso em hábito saudável exige disciplina, clareza e persistência. Não é simples, mas é necessário. Quem mantém o foco colhe menos ruído, mais produtividade, mais bem-estar — e resultados consistentes que realmente fazem a diferença.
Fim de semana, 18 e 19 outubro 2025
Fechamento da edição: 18h
12º | MÁX: 22º O sábado começa com a presença de nuvens e com chuva no Vale.







Toque que salva

Por trás das campanhas, o verdadeiro desafio do câncer de mama está na prevenção, além do acesso ao diagnóstico, ao tratamento igualitário e a reconstrução da vida após a doença.

“As
pessoas se sentem mais à vontade para falar sobre si”
Dra. Luiza Lucas é médica formada pela PUCRS e psiquiatra e psicoterapeuta formada pela HCPA/UFRGS. Atua em consultório particular em Lajeado desde 2020. É professora da Faculdade de Medicina da Univates e preceptora da Residência Médica de Psiquiatria no Hospital São José de Arroio do Meio.
O que te fez escolher a profissão e como foi esse início?
Escolher ser médica foi algo natural. Sou filha de dois médicos — meu pai psiquiatra e minha mãe geneticista — e cresci entre consultórios, plantões e conversas sobre o cuidado com as pessoas. Desde pequena, eu via de perto o quanto o trabalho deles transformava vidas, e isso me encantava. Na adolescência, cheguei a ter dúvidas entre cursar Medicina e Psicologia, porque o que sempre me moveu foi o desejo de escutar e compreender pessoas. Acabei escolhendo Medicina, inspirada também por uma médica que foi minha psicoterapeuta e me ajudou muito nessa fase. Durante a faculdade, me permiti conhecer várias áreas, mas foi em Semiologia, ao conversar com pacientes com doenças graves, que percebi o que realmente me interessava: não apenas o diagnóstico e a patologia física, mas o que aquela doença significava emocionalmente para cada pessoa. A partir dali, entendi que meu caminho seria a Psiquiatria.
Quais os maiores desafios da profissão hoje?
Vejo dois grandes desafios. O primeiro é o acesso: muitas pessoas ainda enfrentam barreiras — sejam financeiras, estruturais ou por estigma — para conseguir atendimento psiquiátrico. Quando chegam ao consultório, muitas vezes já estão em sofrimento intenso, o que torna o tratamento mais difícil. O segundo desafio é o cuidado com a qualidade da assistência. Infelizmente, ainda há profissionais sem a formação adequada atuando na
EXPEDIENTE


área, o que pode comprometer o tratamento e aumentar a desconfiança das pessoas em relação à psiquiatria.
Como você percebe a área hoje e o que nota como evolução daqui pra frente?
A psiquiatria vive um momento de crescimento e transformação. O sofrimento humano sempre existiu, mas hoje as pessoas se sentem mais à vontade para falar sobre isso e buscar ajuda — e isso é uma grande conquista. Acredito que o futuro da psiquiatria está em seguir unindo ciência e sensibilidade. É uma área que se expande sem perder sua essência: compreender o ser humano em
sua complexidade, com escuta, empatia e cuidado genuíno.
Lembra de algum momento marcante de algum paciente que passou por você?
Cada paciente me marca de alguma forma. São histórias, lembranças, dores e superações que se entrelaçam e me ensinam todos os dias. Acredito que uma das maiores ferramentas de cura é o vínculo — a aliança terapêutica entre médico e paciente. Esse foi, inclusive, o tema do meu mestrado. Quando há confiança e entrega dos dois lados (do paciente e do psiquiatra), o tratamento deixa de ser apenas técnico e se torna verdadeiramente transformador.


EDITORIAL
Outubro para além do rosa
Todo ano, o mês de outubro de tinge de rosa e se reforça a importância do autocuidado. Mas o câncer de mama não se resume à cor de uma fita ou à lembrança de um toque. É um tema que pede profundidade. Falar sobre câncer de mama é falar sobre ciência, desigualdade e cuidado contínuo. É discutir acesso ao diagnóstico precoce, aos tratamentos de ponta, ao acolhimento emocional. É entender que, no Brasil, a realidade não é uniforme. Enquanto algumas mulheres têm planos de saúde e fazem mamografias anuais, outras esperam meses por um exame na rede pública. É também falar sobre corpo e identidade. Porque o câncer de mama mexe com o espelho, mas também com o invisível, com a feminilidade, a autoestima, os planos da mulher. A jornada não termina com o fim da quimioterapia. Ela se prolonga na reconstrução
da vida, nas cicatrizes que se tornam parte da história e na coragem silenciosa de quem recomeça.
O desafio, portanto, vai além da prevenção. É fazer com que a informação chegue de forma clara e acessível, que a rede de apoio funcione, que os diagnósticos não demorem. É cobrar do sistema o mesmo comprometimento que se exige das mulheres. Cuidado, atenção. O outubro rosa pode ser bonito, mas precisa ser útil. Que as campanhas inspirem, mas que também provoquem. Que sirvam para lembrar que saúde não é privilégio, é direito. Mais do que um mês de conscientização, que seja um convite ao respeito por cada processo e, em especial, a olharmos para dentro de nós. Boa leitura!
O outubro rosa pode ser bonito, mas precisa ser útil.”
Textos: Bibiana Faleiro Imagens: Paulo Cardoso Diagramação: Lautenir Junior Coordenação: Felipe Neitzke



Tecnovates amplia atuação e prepara hub de saúde

Hospital simulado está entre as novidades oferecidas. Inauguração ocorre na segunda-feira, 20
Odesenvolvimento científico e tecnológico do Vale do Taquari ganha um novo impulso com a criação do Hub Tecno Saúde, estrutura que será inaugurada pela Univates nesta segunda-feira, 20. O espaço integra o Parque Científico e Tecnológico da universidade (Tecnovates) e tem como meta transformar conhecimento em soluções práticas para o setor da saúde, reunindo ensino, pesquisa e empreendedorismo em um mesmo ambiente.
O projeto nasce da consolidação da Univates como uma referência regional na área, resultado de mais de uma década de investimentos em formação e infraestrutura. Com o Hub, a instituição amplia sua atuação, conectando estudantes, pesquisadores e empresas para o desenvolvimento de tecnologias e modelos de gestão aplicáveis ao cotidiano de hospitais, clínicas e serviços públicos.
O novo hub está localizado no prédio 16 do campus e abriga uma série de ambientes dedicados à inovação. Entre eles, coworking, laboratórios de desenvolvimento tecnológico, áreas de prototipagem e impressão 3D e o Hospital de Simulação.


É um projeto que vai gerar um impacto gigantesco nos profissionais de múltiplas áreas. ”
Espaço reúne ciência, prática e tecnologia
Um dos grandes destaques e que tem atraído olhares, é o hospital simulado que fica no primeiro andar do Hub. O hospital conta com salas que reproduzem, com realismo, diferentes contextos de atendimento, desde o acolhimento de pacientes até situações de urgência e alta complexidade. Há espaços que simulam maternidade, bloco cirúrgico, UTI e pronto atendimento, além de uma ambulância simulada destinada ao treinamento de equipes préhospitalares. O ambiente permitirá que estudantes e profissionais dos mais diversos setores testem procedimentos em um cenário controlado, reduzindo riscos e
Hub Tecno Saúde recebeu investimento de R$ 14 milhões
aprimorando a prática clínica. A proposta é formar equipes mais preparadas para lidar com situações reais, desenvolvendo tanto habilidades técnicas quanto a tomada de decisão em momentos críticos.
A gestora da Tecnovates, Criatiani Reimers explica que o hospital é completo e que poderá receber profissionais das mais diversas áreas. “Será possível simular questões de neonatal, de urgência e emergência, de traumas muito graves, poderemos simular uma enfermaria, uma UTI, um bloco cirúrgico, uma sala vermelha e terá laboratório de habilidades que são partes do corpo dos modelos anatômicos. Os modelos interagem com o grupo de profissionais ou com o grupo de alunos.”
Investimento em conhecimento e futuro
Com um investimento de aproximadamente R$ 14 milhões, financiado pela Finep, o Hub Tecno Saúde é mais do que uma nova estrutura física. Ele representa uma estratégia institucional para fortalecer a economia do conhecimento e impulsionar o desenvolvimento regional por meio da inovação.

A expectativa é que, nos próximos cinco anos, o espaço estimule a criação de 50 novas startups e 25 serviços tecnológicos ligados à saúde e às engenharias, promovendo parcerias entre academia, setor produtivo e poder público. Para o pró-reitor de Pesquisa e Pós-Graduação, Luis Fernando Timmers, hub trará um processo inverso do modelo atual, no lugar da pesquisa e inovação ir para os grandes centros, o TecnoSaúde trará para o interior esse capital intelectual.
O projeto também está inserido em uma rede de mais de 200 empresas e instituições que orbitam o ecossistema do Tecnovates. Essa conexão cria

A gente sai do eixo comum da rota de ciência e inovação e coloca a Lajeado no centro principal de desenvolvimento.”
oportunidades de cooperação em pesquisa aplicada, desenvolvimento de produtos e transferência de tecnologia. A ideia é que o Vale do Taquari se consolide como um polo de referência em soluções de saúde integradas à inovação.




Além do laço: prevenção para salvar vidas
Rastreamento precoce, hábitos saudáveis e cuidado diário são aliados ao enfrentamento do câncer de mama
Outubro Rosa marca o mês de conscientização sobre o câncer de mama, mas o desafio da prevenção vai além da campanha anual. No Brasil, a doença continua a atingir milhares de mulheres todos os anos, e o diagnóstico precoce é decisivo para a chance de cura. Novas diretrizes de rastreamento, avanços nos tratamentos e a atenção à saúde física e emocional mostram que a prevenção é um esforço contínuo, que envolve acesso à informação, exames regulares e hábitos de vida saudáveis.
Outubro é o mês em que o tema volta ao centro das conversas, mas, para a médica oncologista Lívia Gravina, o debate sobre o câncer de mama precisa ser constante. “O Outubro Rosa é uma ferramenta de mobilização, mas o cuidado deve ser diário. É a rotina de







prevenção que salva vidas”, afirma.
O câncer de mama é o tipo mais comum entre as mulheres em todo o mundo, exceto pelo câncer de pele não melanoma. No Brasil, segundo o Instituto Nacional de Câncer (INCA), são estimados 75 mil novos casos por ano. E, embora a taxa de cura ultrapasse 90% quando o tumor é descoberto em fase inicial, ainda há desigualdades no acesso ao diagnóstico precoce, um desafio que reflete na sobrevida das pacientes.
“Infelizmente, ainda vemos mulheres chegarem com tumores avançados, muitas vezes por falta de acesso à mamografia ou por medo do resultado. Precisamos vencer essas barreiras”, ressalta Lívia.
Rastrear mais cedo
Neste ano, o Ministério





Cada ano que antecipamos o diagnóstico, salvamos mais vidas. É por isso que ampliar o rastreamento é uma medida de justiça com as mulheres.”
Lívia Gravina oncologista
da Saúde atualizou o protocolo de rastreamento, recomendando que a mamografia passe a ser feita anualmente a partir dos 40 anos, e não mais dos 50, como era até então. A medida acompanha a orientação da Sociedade Brasileira de






A mamografia permite detectar microcalcificações invisíveis ao toque, possibilitando tratamentos menos invasivos e aumentando a chance de cura
Mastologia e do Colégio Brasileiro de Radiologia, refletindo uma mudança importante no perfil da doença.
“Temos visto um aumento na incidência de câncer de mama em mulheres mais jovens, abaixo dos 50 anos. Isso tem relação com fatores hormonais, estilo de vida, alimentação e exposição a substâncias tóxicas. O diagnóstico precoce nessa faixa etária é o que faz a diferença entre um tratamento simples e um tratamento agressivo”, explica a oncologista. De acordo com Lívia, até um quarto dos casos diagnosticados hoje ocorre em pacientes nessa faixa etária. “Por isso, ampliar o rastreamento é uma medida de justiça com essas mulheres. Cada ano que antecipamos o diagnóstico, salvamos mais vidas.”
A médica lembra que lesões pequenas, identificadas apenas por exame de

Com a mamografia, conseguimos identificar alterações muito pequenas, antes mesmo de o câncer causar sintomas. É só uma apertadinha que pode salvar uma vida.”
Marília Macedo Lied radiologista
imagem, têm até 95% de chance de cura. E, quando o tumor é descoberto cedo, muitas vezes é possível evitar quimioterapia e optar por cirurgias conservadoras ou terapias menos tóxicas.
Desafios
Um dos equívocos mais comuns, segundo Lívia, é



tratar o câncer de mama como se fosse uma única doença. “Na verdade, ele é um conjunto de subtipos com comportamentos completamente diferentes”, explica.
Há tumores hormonais, que respondem bem à hormonioterapia e evoluem de forma mais lenta, e há também os chamados triplos negativos, mais agressivos e com evolução rápida, geralmente em mulheres jovens. “É por isso que a personalização do tratamento é fundamental. O que funciona para uma paciente pode não ser eficaz para outra. Hoje a oncologia caminha para a individualização do cuidado”, afirma.
Esse avanço é fruto de décadas de pesquisa e da chegada de novas terapias,

curar a doença, mas de cuidar da mulher como um todo, com hábitos saudáveis e acompanhamento multidisciplinar.”
Daiane Coltro, mastologista
saúde mental da mulher. “Não existe cura completa se não olharmos para a mulher como um todo. A doença mexe com a feminilidade, com o medo, com a relação com o próprio corpo”.
mulheres ainda terem receio do exame, Marília garante que ele é rápido, seguro e praticamente indolor. “É só uma apertadinha que pode salvar uma vida”, resume. A médica destaca que o acesso ao exame está cada vez mais fácil, tanto na rede pública quanto na privada, e que a conscientização precisa ir além do Outubro Rosa. “O importante é transformar o exame em rotina, uma vez por ano. Quando a mulher faz isso, está cuidando de si mesma e dando um passo decisivo na prevenção do câncer de mama.”
Estilo de vida

Sobre a doença
- O câncer de mama é o mais comum entre as mulheres, depois do câncer de pele não melanoma.
- A mamografia é o único exame comprovadamente eficaz no diagnóstico precoce.
como os inibidores de ciclina, anticorpos monoclonais e imunoterápicos. “São medicamentos que transformaram o prognóstico de muitos tipos de câncer, inclusive o de mama. O desafio é garantir que todas as mulheres tenham acesso a eles.”
Apesar dos avanços, o Brasil ainda enfrenta grandes disparidades regionais no diagnóstico e no tratamento. Em muitas cidades, a mamografia continua sendo um exame de difícil acesso pelo SUS, e o intervalo entre o pedido médico e o resultado pode ultrapassar meses.
Olhar integral
Lívia também lembra que o câncer de mama tem impacto profundo na autoestima e na
Ela defende o acompanhamento multidisciplinar, com mastologistas, oncologistas, fisioterapeutas, nutricionistas e psicólogos. “Uma paciente bem acolhida, com apoio emocional e orientação adequada, enfrenta o tratamento com muito mais força e adesão”, destaca.
Diagnóstico precoce
A mamografia é uma das principais aliadas na prevenção e detecção precoce do câncer de mama. “Com a mamografia, conseguimos identificar alterações muito pequenas, antes mesmo de o câncer causar sintomas, o que aumenta significativamente as chances de cura”, explica a médica radiologista Marília Macedo Lied.
Segundo a especialista, a mamografia permite detectar microcalcificações invisíveis ao toque e, em muitos casos, possibilita tratamentos menos invasivos, como apenas radioterapia, sem necessidade de cirurgia. Apesar de algumas
A mastologista Daiane Coltro também destaca que a mamografia é insubstituível. A ecografia mamária, muito solicitada, deve ser usada como exame complementar, e não isolado. “Ela serve para investigar alterações vistas na mamografia. Sem a mamografia, pode-se deixar passar lesões pequenas”, esclarece.
Outro ponto importante é a mudança de conduta sobre o autoexame. O Ministério da Saúde não recomenda mais a prática como método de rastreamento. “Quando o nódulo já é palpável, o câncer pode estar em estágio mais avançado. A mamografia é essencial justamente porque detecta tumores que ainda não causam sintomas.”
A prevenção também passa por hábitos saudáveis. Daiane lembra que atividade física regular, controle de peso e moderação no consumo de álcool são atitudes que reduzem o risco de desenvolver a doença.
“Cerca de 30% do risco de câncer de mama pode ser reduzido com a prática de atividade física de moderada intensidade, uma hora, três vezes por semana, já faz diferença“, afirma.
A médica destaca a importância do trabalho em equipe multidisciplinar para garantir qualidade de vida durante e após o tratamento.
- O Ministério da Saúde recomenda o exame anual a partir dos 40 anos.
- 30% dos casos podem ser evitados com atividade física regular e alimentação equilibrada.
- O autoexame não substitui a mamografia.
- Homens também podem ter câncer de mama — cerca de 1% dos casos.
Quando fazer a mamografia
- A mamografia deve ser feita anualmente a partir dos 40 anos, segundo o novo protocolo do Ministério da Saúde.
- Mulheres com histórico familiar de câncer de mama devem iniciar o rastreamento antes dos 40, conforme avaliação médica.
- O exame deve ser realizado mesmo na ausência de sintomas. Quanto antes o diagnóstico, maiores as chances de cura.
- O autoexame não substitui a mamografia, mas ajuda a conhecer o corpo e perceber alterações.








Baixa adesão às vacinas ameaça avanços da saúde
Especialistas
alertam para o risco de reintrodução de doenças já erradicadas e reforçam a importância da imunização como ferramenta coletiva de proteção
Aqueda na adesão às vacinas ameaça os avanços da saúde pública e acende um alerta sobre o retorno de doenças já erradicadas, além de colocar em xeque a capacidade do sistema em conter novos surtos. Dados do Ministério da Saúde revelam que a procura por imunização vem diminuindo desde 2016, após 15 anos de estabilidade. Segundo a coordenadora da Vigilância Epidemiológica de Lajeado, Juliana Demarchi, a redução dos índices pode estar associada a diversos fatores, entre eles, a falsa sensação de segurança de que determinadas doenças não existem mais. Ela alerta, no entanto, para o ressurgimento de casos de sarampo e poliomielite em países vizinhos.
“Não podemos contar com fronteiras geográficas. A população circula, e a única forma de mantermos essas doenças controladas é por meio da vacinação. É fundamental que a cobertura não continue em queda, para evitar que enfermidades graves sejam reintroduzidas em nossa sociedade, causando sequelas e vitimando vidas”, reforça Juliana.
Em Lajeado, o cenário preocupa. A meta é alcançar 95% de cobertura vacinal, mas nenhuma das vacinas aplicadas em crianças com menos de um ano atinge esse índice. Entre as menores taxas estão Febre Amarela (80,25%), Poliomielite (84,63%) e Hepatite B (84,88%).
Entre crianças com um

Serviço
O quê:
Quando:
Horário:

ano de idade, os números melhoram, mas ainda ficam abaixo do ideal. A Tríplice Viral (2ª dose) apresenta 90,13% de adesão, seguida da Varicela (91%) e da Tríplice Bacteriana Infantil – 1º reforço (92,38%).
A preocupação do Ministério da Saúde se intensifica diante do rastreamento de cepas ultra-resistentes a antibióticos, o que amplia o risco de retorno de vírus e enfermidades antes controladas.
Juliana também destaca a importância da vacina contra o HPV, disponível para meninos e meninas de 9 a 14 anos. “A cobertura não alcança 90% em nenhum dos grupos. Segundo nossos registros, 88% das meninas foram imunizadas, enquanto apenas 73,33% dos meninos receberam a vacina”, aponta.
“Muitos associam a vacina ao câncer de colo de útero e, por isso, acabam desconsiderando a importância da imunização dos meninos”, explica. “Mas é fundamental lembrar que eles também podem transmitir o vírus, além de estarem suscetíveis a desenvolver câncer de pênis, boca e garganta.”
Em Lajeado, o cenário preocupa. A meta é alcançar 95% de cobertura vacinal, mas nenhuma das vacinas aplicadas em crianças com menos de um ano atinge esse índice
Dia D em Lajeado
Com o objetivo de ampliar as coberturas vacinais e atualizar a situação de crianças, adolescentes e adultos, o Dia D de Vacinação ocorre neste sábado, 18 de outubro, das 8h às 14h, na Unidade de Saúde do Centro, em Lajeado. A mobilização integra a estratégia de atualização das cadernetas vacinais, em vigor entre os dias 6 e 31 de outubro.
Em parceria com a Secretaria de Saúde, o evento contará com o apoio dos quatro Rotary Clubs de Lajeado, que promoverão atividades recreativas e brinquedos infláveis para as crianças. As ações acontecem em frente à unidade, com bloqueio do trânsito de veículos entre a Avenida Benjamin Constant e a Rua Júlio de Castilhos.
Lajeado

coordenadora Epidemiológica
Onde: Unidade de Saúde do Centro – Rua Cel. Júlio May, 383 –
Serviço: Vacinação, coletas de citopatológico, solicitação de mamografia, testes rápidos, verificação de pressão arterial, orientações nutricionais e aula de ginástica+
Levar: Documento e se possível Carteira de Vacinação


Raíssa Zanatta
Nutricionista CRN2 18830

Mulheres de fases
“Somos, literalmente, mulheres de fases. Em alguns momentos, damos conta de tudo: trabalho, casa, treinos, rotina... Em outros, o cansaço e a irritação parecem tomar conta. E está tudo bem”, afirma a nutricionista Raíssa Zanatta. De acordo com a profissional, nosso corpo e nossas emoções mudam ao longo do mês. Durante esse período, passamos por diferentes etapas do ciclo menstrual, e cada uma delas traz sintomas, sensações e necessidades diferentes.
A primeira é a fase folicular, que dura em torno de 14 dias e inicia com a menstruação. Ela é marcada pela renovação, é o momento em que a energia tende a aumentar e a disposição melhora (inclusive, é uma ótima fase para iniciar novos hábitos ou atividades físicas).
A segunda é a fase ovulatória, que dura de 1 a 3 dias e representa o auge da fertilidade, da autoconfiança e do bem-estar. Muitas mulheres se sentem mais motivadas, comunicativas e produtivas nesse período.
Por fim, vem a fase lútea, com duração aproximada de 14 a 15 dias. Nela, o corpo se prepara para uma possível menstruação, e é quando podem surgir os sintomas da TPM como: irritabilidade, sensibilidade emocional, inchaço e, claro, o aumento da fome e da vontade de comer doces.
“Entender essas fases é fundamental para acolhermos nosso corpo com mais leveza, sem tantas cobranças. Nem todos os dias precisam ser produtivos ou perfeitos, e tudo bem querer um docinho.”
Pensando em passar por essa fase do ciclo de forma mais tranquila, sem sair da dieta, Raíssa preparou uma receitinha doce, proteica e equilibrada.

Bombom Prestígio saudável
Ingredientes
• ½ copo de iogurte natural
• 2 colheres (sopa) de coco ralado sem açúcar
• 3 colheres (sopa) de whey protein
• 1 barra de chocolate 70% cacau
Modo de preparo
Em um recipiente, misture o iogurte natural, o coco ralado e o whey protein até formar uma massa consistente. Com o auxílio de uma colher, modele pequenas porções e coloqueas em um prato. Leve ao freezer por pelo menos 30 minutos. Enquanto isso, derreta o chocolate 70% cacau no microondas (a cada 30 segundos, mexendo para não queimar).
Mergulhe as porções congeladas no chocolate derretido e leve novamente ao freezer até firmar.
Dica: conserve em pote fechado no congelador e saboreie quando quiser um docinho saudável








Uma em cada seis infecções são resistentes a antibióticos
Dados são do novo Relatório Global de Vigilância da Resistência aos Antibióticos 2025 da ONU
AOrganização
Mundial da Saúde (OMS) lançou na segunda-feira, 13, o novo Relatório Global de Vigilância da Resistência aos Antibióticos 2025. O documento apresenta, pela primeira vez, estimativas de prevalência de resistência em 22 antibióticos usados no tratamento de infeções urinárias, gastrointestinais, sanguíneas e gonorreia.
O documento abrange oito patógenos bacterianos comuns, todos associados a uma ou mais destas infecções.
Os dados, reportados ao Sistema Global de Vigilância da Resistência e do Uso de Antimicrobianos da OMS, alertam que o aumento da resistência a antibióticos essenciais representa uma ameaça crescente à saúde global.
Entre 2018 e 2023, a resistência antimicrobiana aumentou em mais de 40% das combinações de patógeno e antibiótico monitoradas, com um crescimento médio anual entre 5% e 15%.

A OMS estima que a resistência a antibióticos é mais elevada no Sudeste Asiático e no Mediterrâneo Oriental, onde uma em cada três infecções reportadas era resistente, e na África, onde uma em cada cinco apresentou resistência.
O relatório ainda destaca que as bactérias resistentes a medicamentos estão se tornando cada vez mais perigosas, com o maior impacto nos países menos preparados para responder. Entre elas, “E. coli” e “K. pneumoniae” são as principais encontradas em infecções sanguíneas, frequentemente associadas à infecção generalizada, falência de órgãos e morte. Mais de 40% das estirpes de E. coli e mais de 55% de K. pneumoniae a nível global já são resistentes à primeira escolha de tratamento para estas infecções.
Ação coordenada até 2030
A agência da ONU apela a todos os países que, até 2030, apresentem dados de alta qualidade sobre resistência e uso de antimicrobianos. Para atingir este objetivo, será necessário melhorar a
OMS estima que a resistência a antibióticos é mais elevada no Sudeste Asiático e no Mediterrâneo Oriental


qualidade, a cobertura geográfica e a partilha de dados de vigilância, permitindo acompanhar o progresso global. Os países devem intensificar intervenções coordenadas em todos os níveis dos cuidados de saúde e garantir que as listas de medicamentos essenciais e as diretrizes terapêuticas estejam alinhadas com os padrões locais de resistência. O relatório é acompanhado por conteúdos digitais ampliados disponíveis no painel da OMS, que oferece resumos globais e regionais, perfis de países e informações detalhadas sobre o uso de antimicrobianos.


Vitamina D em equilíbrio
Essencial para ossos, imunidade e metabolismo, a vitamina D precisa ser obtida com cuidado. Tanto a falta quanto o excesso podem causar prejuízos à saúde
Avitamina D é uma das substâncias mais importantes para o bom funcionamento do corpo humano. Apesar de ser chamada de “vitamina”, ela atua como um pré-hormônio, regulando a absorção de cálcio e fósforo, minerais importantes para o fortalecimento dos ossos e dentes. Além disso, participa da modulação do sistema imunológico, da função muscular e até de processos metabólicos e cardiovasculares, segundo o Ministério da Saúde. Grande parte da necessidade diária dessa vitamina pode ser suprida de forma natural, por meio da exposição ao sol. Quando os raios UVB entram em contato com a pele, o organismo produz a vitamina D. Em menor proporção, ela também é encontrada em alimentos como peixes gordurosos (salmão, sardinha e atum), gema de ovo, fígado e produtos fortificados. Entretanto, a carência da vitamina é comum, especialmente em pessoas
que passam pouco tempo ao ar livre, vivem em regiões com menor incidência solar ou têm restrições alimentares.
A deficiência pode causar fadiga, fraqueza muscular, dor óssea e aumentar o risco de doenças como osteoporose e raquitismo.
O uso indiscriminado de suplementos de vitamina D, no entanto, pode trazer riscos graves. De acordo com a Vigilância em Saúde do Rio Grande do Sul, doses elevadas e sem prescrição médica podem causar hipercalcemia, o excesso de cálcio no sangue, levando a náusea, desidratação, confusão mental e até lesões nos rins. Um caso recente no Reino Unido ganhou destaque depois que um homem foi hospitalizado por intoxicação, com níveis sete vezes acima do recomendado, após automedicar-se com cápsulas de vitamina D. Para garantir o equilíbrio, especialistas recomendam exames periódicos para avaliar os níveis da substância no sangue e, se necessário,

Vitamina em dia
- Exponha-se ao sol com moderação: 15 a 20 minutos por dia, preferencialmente antes das 10h ou após as 16h.
- Inclua alguns alimentos na rotina: salmão, sardinha, gema de ovo, fígado e leite.
- Faça o uso de suplementos apenas sob orientação médica: evite automedicação e faça exames antes de iniciar o uso.
- Cuidado com o excesso: níveis muito altos podem causar danos renais e desequilíbrios metabólicos.
ajustar a dose sob orientação médica. Sol na medida certa, alimentação equilibrada e cuidado com a suplementação são os pilares para aproveitar os benefícios dessa vitamina sem colocar a saúde em risco.




Tecnologia amplia colaboração para atender crianças com TEA

Dados para tomada de decisão e gestão das terapias são algumas das funcionalidades aplicadas por healthcare
Atecnologia tem revolucionado a área da saúde no Brasil, gera benefícios para pacientes, profissionais e para o sistema como um todo. No caso do atendimento a crianças com Transtorno do Espectro Autista (TEA), essa revolução tecnológica se torna ainda mais relevante. O cuidado exige seriedade e respeito, já que cada paciente apresenta necessidades específicas que não podem ser tratadas de forma genérica. Atenta à importância de abordagens planejadas, a Unimed Vale do Taquari e Rio Pardo (VTRP), firmou parceria com a NeuroSteps, healthtech catarinense especializada na gestão de terapias especiais e modelos de cuidado, para ampliar e qualificar o atendimento de mais de 500 crianças com Transtorno do Espectro Autista (TEA).
A parceria marca um avanço na forma como a Unimed VTRP conduz o cuidado integral, ao

integrar um software de gestão totalmente conectado aos fluxos assistenciais, que apoia a tomada de decisão baseada em evidências científicas.
Antes da adoção da ferramenta, a cooperativa enfrentava desafios como fragmentação de dados, análises manuais demoradas e limitações no acompanhamento da evolução dos pacientes. Hoje, a equipe clínica dispõe de painéis com indicadores de produtividade, assiduidade e desfechos terapêuticos — permitindo maior eficiência e precisão no cuidado. “O acesso em tempo real sobre a evolução dos pacientes nos ajuda a agir com confiança, refletindo na melhor decisão e intervenções”, explica Viviane Reis, gerente da clínica da Unimed VTRP dedicada ao cuidado de crianças com TEA.
A tecnologia também trouxe ganhos administrativos expressivos: 91% do tempo antes destinado à produção de relatórios foi redirecionado a atividades estratégicas e atendimentos, otimizando o uso da estrutura e ampliando o tempo das equipes para as terapias.
Além disso, as famílias agora acompanham a jornada terapêutica por meio de
um aplicativo, que funciona como canal direto e on-line de acompanhamento. Nele, os familiares acompanham a evolução do paciente em tempo real, já que os dados registrados ficam imediatamente disponíveis, facilitando a comunicação com a clínica.
A aproximação entre as duas empresas começou no programa de aceleração Vibee Unimed, hub de inovação da operadora — reconhecida nacionalmente por suas iniciativas de inovação aberta. Após um piloto com 20 pacientes dentro do programa InnovatiON, a parceria foi formalizada e ampliada para toda a rede.
Segundo Ivan Junckes Filho, CEO da NeuroSteps, a iniciativa evidencia o papel transformador da tecnologia no cuidado em saúde: “Mais do que uma ferramenta para gestão de terapias especiais, o suporte, o treinamento contínuo e a capacitação da equipe são indispensáveis na jornada de cuidado de pacientes com TEA”, afirma.
Sobre a Unimed VTRP
Melhor operadora de planos de saúde do Brasil conforme o Índice de Desempenho da Saúde Suplementar (IDSS) 2024, a Unimed Vales do Taquari e Rio Pardo (Unimed VTRP) cuida da saúde de mais de 240 mil vidas entre os clientes do plano de saúde e demais produtos e serviços do Grupo Econômico Unimed VTRP. Com quase 800 médicos cooperados, é destaque no Rio Grande do Sul e líder de mercado em sua área de atuação, com cerca de
70% de Market Share nos vales do Taquari, Rio Pardo e Região do Jacuí. Reconhecida nacionalmente pela inovação, conta, desde 2019, com programas de conexão e aceleração de startups através do hub Vibee Unimed.
Sobre a NeuroSteps
A catarinense NeuroSteps é uma healthtech especializada em estruturar modelos de cuidado para crianças com Transtorno do Espectro Autista (TEA). A empresa desenvolve soluções que integram tecnologia, ciência e assistência nas terapias especiais.


Lente Social
Fórum
da Mulher discute equilíbrio feminino
O Fórum da Mulher
Empresária (FME), da Associação Comercial e Industrial de Lajeado (Acil), encerrou o ciclo de cafés 2025 nesta terça-feira, 14. Na pauta, um debate sobre a importância de manter o equilíbrio nas diferentes áreas da vida feminina. As
palestrantes da vez foram a psicóloga e teóloga Rosane Pagliarin Tünnermann e a médica ginecologista Maiticia Hoppe. O evento reuniu cerca de 50 empreendedoras e profissionais de empresas da região para um momento de inspiração e troca de experiências.







Inspiração no exterior

Fernando Röhsig, conselheiro de administração, reuniu diversos empresários para uma palestra em que compartilhou sobre suas experiências em centros mundiais de negócios, inovação e gestão, com vivências no Vale do Silício, Inglaterra, China e

Imersão na cultura mineira


Carmen Helena Dresch e sua equipe realizaram a 2º edição do Senses 2025 - Minas, que nesta etapa levou os convidados para uma experiência sensorial para mergulhar na cultura mineira. Durante o dia, os participantes

puderam realizar um circuito com 15 estações para vivenciar experiências, conexões e negócios com fornecedores e parceiros. O evento ocorreu na quinta-feira, 16, na Arabesco Acabamentos e finalizou com uma bela festa de encerramento.



Gabriela Luísa Bresolin
Gabriela Bresolin
Arquitetura e Interiores (51)98929 0727
@gabriela.bresolin (instagram) gabrielalbresolin@ gmail.com (e-mail)
Um projeto para brindar bons momentos.
Assim foi o trabalho da arquiteta Gabriela Bresolin, do escritório Gabriela Bresolin Arquitetura e Interiores, que transformou um espaço livre da sala em um ambiente funcional e acolhedor para um cliente amante de vinhos.
Com inspiração em enotecas contemporâneas, onde iluminação, materiais naturais e organização se unem para valorizar cada rótulo, foram utilizados revestimentos em pedra natural Travertino, que, combinados à iluminação focada e difusa, criam uma atmosfera intimista.
Estruturas metálicas iluminadas evidenciam garrafas especiais, enquanto a cristaleira exibe taças e peças decorativas. O espaço conta ainda com nicho para adega climatizada, gavetas inclinadas que mantêm os vinhos visíveis, além de um pequeno bar para bebidas destiladas e utensílios de apoio.
O resultado é um ambiente que combina elegância e aconchego, feito sob medida para brindar bons momentos ao lado de quem amamos e criar memórias inesquecíveis.
Entre vinhos e memórias


Estruturas metálicas iluminadas evidenciam garrafas especiais, enquanto a cristaleira exibe taças e peças decorativas

